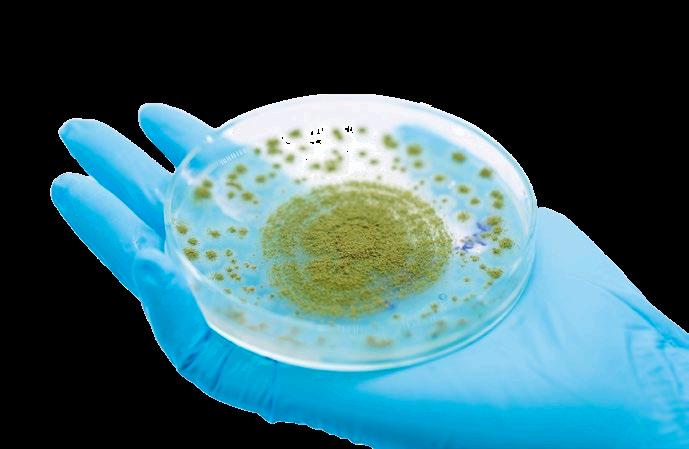

EL DESHUESADOR DE MUSLOS MÁS COMPACTO DEL MERCADO.



EL DESHUESADOR DE MUSLOS MÁS COMPACTO DEL MERCADO.


06 16
Principios de bioseguridad en avicultura con énfasis en el control del síndrome entérico - Una nueva mirada
Dra. Masaio Mizuno Ishizuka Profesora Titular de Epidemiología de Enfermedades Infecciosas de la Facultad de Medicina Veterinaria y Zootecnia de la Universidad de São Paulo (FMVZ-USP).


¿Estamos preparando las granjas para los efectos del aumento de temperaturas y el calor extremo?
Jose Luis Januário


Cobb-Vantress Especialista en pollos de engorde y ambientes para Sudamérica
22 30
Comunicaciones Inconsistentes y Ceguera Gerencial: ¿Cómo afectan la calidad y el rendimiento de los pollos procesados?
Eduardo Cervantes López Consultoría Internacional - Gerencia Productiva e Innovadora en Procesamiento de Aves

Cómo obtener el máximo beneficio de una Prueba de Sensibilidad Anticoccidiana (AST)
Héctor M. Cervantes1 y Larry R. McDougald2
1Departamento de Salud Poblacional, Facultad de Medicina Veterinaria, Universidad de Georgia, Athens, Georgia, EE.UU.
2Departamento de Ciencias Avícolas, Facultad de Agricultura y Ciencias del Medio Ambiente, Universidad de Georgia, Athens, Georgia, EE.UU.
Experiencia en uso de SPIDES en incubadoras de etapa única

Fernando Aguet1 e Ing. Andrea Dribin2


1Encargado de la Planta de incubación, Las Camelias
2Universidad Nacional de Entre Ríos, Argentina
Diferentes metodologías de tratamiento de la cáscara de huevo: Impactos sobre la calidad física y microbiológica de huevos comerciales

Alicia Dal Santo, Vanessa Forcellini, Ana Paula Gonzatti, Lucas Zanella, Gustavo S. Hoepfner, Milena P. Marin, Bruna B. Caus, Fernanda
Danieli A. Valentini, Heloisa Pagnussatt, Lilian K. Girardini, Tiago Goulart Petrolli y Eduarda da Silva
Universidad del Oeste de Santa Catarina, Brasil
Edgar O. Oviedo Rondón1 , Anneliese Mueller2 y Bettina Behler-Wöcht 2










1Prestage Department Poultry Science, North Carolina State University, Raleigh, NC, USA




2DSM firmenich, Getzersdorf, Austria
MV Cecilia Rodríguez
Luis Abarca-Blanco1 y Otávio Antônio Rech2
1Veterinario avícola en Trouw
Nutrition Latam
2Nutricionista avícola en Trouw



Nutrition Latam

Volker Altenbokum1 y Alan Lee2
1Director de Desarrollo de Negocios Internacionales

2Director de Desarrollo de Negocios Nacionales
Equipo Técnico de BioZyme Inc.
Juan D. Latorre1 , Sakine





Yalçin
Isaias1
1Departamento de Ciencia Avícola, Universidad de Arkansas, EE.UU
2Departamento de Nutrición Animal y Enfermedades Nutricionales, Facultad de Medicina Veterinaria, Universidad de Ankara, Turquía
3Instituto de Enfermedades Avícolas, Facultad de Medicina Veterinaria, Universidad Libre de Berlín
M.V. M.Sc. Dino Garcez1 y M.V. Letícia Tonoli Braga2
1Consultor Técnico/ DGbioss

2Gerente Técnica de Ventas Experta en


El primer Latin American Poultry & Nutrition Congress, LPN, se llevó a cabo en el Centro de Convenciones del Aeropuerto de Miami (Miami Airport Convention Center) en octubre de 2018, por iniciativa del Grupo de Comunicaciones Agrinews, empresa editorial especializada en el área pecuaria y comunicación en empresas agroalimentarias, con sede en Barcelona, España. Dicho congreso tuvo gran éxito, reuniendo a más de 1.500 convencionistas. Lamentablemente, dos años más tarde no se pudo realizar debido a la pandemia por COVID-19.

Por ello, el LPN se aplazó al año 2021 con excelentes resultados y volviéndose en punto de referencia para todo el sector latinoamericano de avicultura y nutrición animal.
Ya este 2023, nos aprestamos a celebrar el tercer congreso LPN Congress & Expo en octubre del 2023.
Los objetivos del Congreso LPN, así como de la Revista aviNews Latam, son llevar a cabo la extensión del conocimiento académico y científico, buscando la capacitación y actualización técnico-científica de profesionales, tales como médico veterinarios, ingenieros agrónomos, nutriólogos, zootecnistas, genetistas y otros especialistas del área de las Ciencias Avícolas, así como, la
La producción mundial de carne de pollo en 2022 fue de 100,9 millones de toneladas y la producción global de huevo para el plato en el mismo año, fue de 87,6 millones de toneladas, según la FAO.
Estas cifras demuestran que la principal proteína de origen animal consumida por la humanidad en el mundo actualmente proviene de la industria avícola.
De acuerdo con estimaciones de la Organización de las Naciones Unidas para la Alimentación y la Agricultura (FAO) y la Organización para la Cooperación y el Desarrollo Económicos (OCDE), durante la siguiente década habrá un incremento del 16% en el consumo de carne de pollo a nivel mundial.
Es decir, para 2031, 47% de la carne que se consumirá en todo el mundo procederá de esta ave debido a su alto nivel nutricional y a su bajo costo, en comparación con otras proteínas como la carne de res y cerdo.
El aumento en el consumo de la carne de pollo será de 154 millones de toneladas de carne.
Los organizadores del LPN de Miami 2023, esperan una participación de más de 2.000 visitantes.
EDITOR
GRUPO DE COMUNICACIÓN AGRINEWS S.L.
DISEÑO GRÁFICO & WEB
Marie Pelletier
Enrique Núñez Ayllón
PUBLICIDAD
Luis Carrasco +34 605 09 05 13 lc@agrinews.es

Karla Bordin +55 (19) 98177-2521 mktbr@grupoagrinews.com
Nicole Carletti +57 312 391 9330 avinewslatam@grupoagrinews.com
ATENCIÓN AL CLIENTE
Mercé Soler
REDACCIÓN
José Luis Valls
Osmayra Cabrera
Daniela Morales
Maria de los Angeles Gutiérrez
Nicole Carletti
DIRECCIÓN TÉCNICA
Dr. Miguel A. Márquez, DVM, MSc, PhD, Diplomate ACPV
Patólogo Aviar/Avian Pathologist
FMVZ/UNAM
Ing. Eduardo Cervantes
Consultor internacional de procesamiento avícola
Dr. Guillermo Díaz Arango
Consultor técnico internacional en gallinas de postura
Mário Penz Jr.
Winfridus Bakker
Juan Carlos López
Mike Czarick
Brian Fairchild
COLABORADORES info@grupoagrinews.com avinews.com grupoagrinews.com
Revista de distribución gratuita
DIRIGIDA A VETERINARIOS Y TÉCNICOS
Depósito Legal Avinews B11597-2013
ISSN (Revista impresa) 2696-8223
ISSN (Revista digital) 2696-8231
Precio de suscripción anual: 90 USD
Imágenes: Noun Project / Freepik/Dreamstime
El gran evento Latinoamericano sobre Avicultura y Nutrición Animal

En la profilaxis de enfermedades infecciosas en poblaciones avícolas, en el contexto de la sanidad animal, ya sea de prevención o control, siempre va dirigida a la población de una determinada zona geográfica (Sanidad Animal) o a un establecimiento de producción (Medicina Preventiva Veterinaria/Bioseguridad) y el requisito fundamental para su implementación es el conocimiento de la epidemiología de las enfermedades transmisibles.
 Dra. Masaio Mizuno Ishizuka Profesora Titular de Epidemiología de Enfermedades Infecciosas de la Facultad de Medicina Veterinaria y Zootecnia de la Universidad de São Paulo (FMVZ-USP).
Dra. Masaio Mizuno Ishizuka Profesora Titular de Epidemiología de Enfermedades Infecciosas de la Facultad de Medicina Veterinaria y Zootecnia de la Universidad de São Paulo (FMVZ-USP).
Se trata de la ciencia que estudia los mecanismos de transmisión de enfermedades en poblaciones animales y las medidas de profilaxis que, para su aplicación, es necesario conocer el agente etiológico involucrado, el huésped y el medio ambiente.
Es la capacidad de resolver problemas con conciencia, aprendiendo cómo pensar y no qué pensar para delinear un programa de salud avícola.
Sin la epidemiología no hay base científica para la práctica de la Sanidad Animal y la Bioseguridad.


El foco de la clínica es el animal enfermo, es como mirar un árbol enfermo. Su finalidad es el tratamiento.
El foco de la patología es una parte del animal (lesiones macroscópicas y microscópicas, suero sanguíneo, fragmentos de órganos) con el objetivo de estudiar el camino que un agente patógeno recorre en el organismo de un animal infectado o enfermo. Es como mirar la madera de un árbol enfermo.
El foco de la epidemiología es el entorno donde viven los animales (granja) y los alrededores donde están presentes los factores de riesgo (animales silvestres y domésticos en libertad), granjas de traspatio, captaciones de agua (ríos, lagos, embalses), vertederos sanitarios, basurales, roedores, insectos, etc.
Figura 1. Representación de los pilares de la práctica clínica, patología y epidemiología. La clínica estudia animales enfermos La patología estudia animales muertos y/o partes de estos y de los enfermosPor lo tanto, las medidas de bioseguridad se refieren a acciones en los diferentes componentes del medio ambiente.
Un programa de control de enfermedades debe estar bien diseñado tanto desde el punto de vista biológico (efectividad) como económico (eficiencia). También debe ser dinámico para evolucionar de acuerdo con las alteraciones de la situación evaluada por la frecuencia de ocurrencia de la enfermedad/infección, las condiciones económicas (costobeneficio), políticas o socioclimáticas que requieren un cambio en el curso del programa.
Son objeto de este documento las aves de producción comercial sin énfasis específico en las diferentes modalidades alternativas tales como pollos de engorde criados en libertad, gallinas ponedoras comerciales libres de jaulas.
Se los mencionará simplemente como patógenos o agentes de enteritis porque en el enfoque epidemiológico serán tratados como agentes de enfermedades entéricas, a pesar de que cada agente está representado por innumerables especies. Se caracterizan por ser eliminados a través de las heces, ser altamente resistentes a las condiciones ambientales en las que permanecen viables durante meses y entrar en el organismo de un nuevo huésped por la boca, de ahí la denominación de enfermedades de transmisión oral fecal.
Hospedadores
Los agentes de enteritis carecen de especificidad de huésped. Este conocimiento nos concede autoridad científica para controlar el conjunto de agentes que causan el síndrome entérico en una población e invalida cualquier procedimiento de control dirigido a uno o unos pocos agentes etiológicos. Tomando solo las salmonellas como ejemplo, se ha descubierto que infectan a más de 2.600 especies de huéspedes de sangre fría y caliente.



Medio Ambiente
La relación huésped-parásito es modulada por el ambiente en sus más diversos componentes, tales como condiciones socioeconómicas (pobreza y riqueza; nivel de educación), clima, naturaleza del suelo, vegetación, bosques (presencia de animales depredadores, aves silvestres, animales silvestres), naturaleza de la explotación animal (cría de aves solamente o mezclada con otras especies animales), presencia de criaderos free range y de traspatio, etc. El equilibrio de la relación hospedero-parásito se conquista cuando el ambiente favorece la producción de aves que es objeto del programa y cuando es desfavorable, la avicultura pasa a enfrentar un aumento en la ocurrencia de enfermedades y los daños se manifiestan.


Cabe destacar que en la profilaxis de enfermedades (erradicación, prevención y control) las medidas se aplican a los diferentes componentes del medio ambiente.
Cuando las medidas de profilaxis equilibran las fuerzas defensivas del huésped y las fuerzas ofensivas del medio ambiente, la enfermedad se manifiesta a un nivel controlado, como se muestra en la figura de abajo, y la productividad no se ve comprometida. El equilibrio entre los platos ilustra el equilibrio entre las fuerzas defensivas del huésped y las fuerzas agresivas del medio ambiente.
Cadena de transmisión de las enfermedades que constituyen el síndrome entérico.



FUENTE DE INFECCIÓN
Aves domésticas y de vida libre, incluidas las aves silvestres que albergan el parásito en su organismo y lo liberan al medio ambiente. Pueden ser enfermos, portadores (sanos, en incubación o convalecientes y reservorios) -aves de otras especies y animales domésticos y salvajes;
VÍAS DE ELIMINACIÓN
Medio o vehículo que utiliza el parásito para llegar al medio ambiente. Son las heces;
VÍAS DE TRANSMISIÓN
Medio o vehículo que utiliza el parásito para ingresar al nuevo huésped. Son el agua, alimento, cama, moscas, escarabajos, botas, manos contaminadas por el parásito;

PUERTA DE ENTRADA
Acceso del parásito al nuevo huésped, que es la boca;
SUSCEPTIBLE
Nuevo huésped a ser infectado;





En ausencia de medidas de control efectivas, este ciclo se repite inde nidamente en la población, resultando en un aumento gradual de la prevalencia.

La cadena de transmisión o cadena epidemiológica consta de los siguientes eslabones:
Medidas relativas a las fuentes de infección
Tratamiento de aves cuando corresponda y eliminación del lote cuando así lo establezca la legislación (salmonella).


Medidas relativas a las vías de transmisión
Vallas sobre los muros para impedir el ingreso de animales fuera del criadero; barrera sanitaria (portón sanitario) e higiene de empleados y visitantes); limpieza de áreas exteriores al galpón (énfasis en roedores y moscas); tratamiento completo de agua de bebida, almacenamiento y redes de distribución; recogida y eliminación adecuada de desechos y animales muertos; limpieza y desinfección del piso, comederos, bebederos, cortinas en el vacio sanitario; control de escarabajos en el vacío sanitario; Prevención y control de plagas (roedores, moscas y escarabajos durante el alojamiento).
Medidas relativas a los susceptibles
Vacunas cuando estén disponibles.
2
Definición de los objetivos inicial, intermedio y final. Redactar Manual de Procedimientos y elaborar fichas de procedimiento operativo estándar (POE);
Objetivo Inicial: introducir medidas de bioseguridad;
Objetivo intermedio: reducir la morbilidad y/o mortalidad y aumentar la productividad;
Objetivo final o propósito: mejorar las condiciones de salud de las aves.


1 bioseguridad aviNews América Latina Septiembre 2023 | Principios de bioseguridad en avicultura con énfasis en el control del síndrome entérico - Una nueva mirada

Fase de ataque: aplicación continua y sistemática de procedimientos. Implica evaluar periódicamente para corregir el rumbo.
Fase de consolidación: llegar al objetivo final, ajustando las medidas de bioseguridad para que no ocurra rebrote de infecciones o enfermedades.


Fase de mantenimiento: continuación de la fase anterior, pero integrándola en el Plan de Sanidad Animal del establecimiento o zona.

Evaluación: realizar evaluaciones periódicas, no sólo realizando pruebas de laboratorio para evaluar la presencia o ausencia del patógeno, sino principalmente mediante el análisis estadístico de indicadores de salud (morbilidad, mortalidad); indicadores de producción.
Las pruebas estadísticas son bastante sencillas, como la prueba de diferencia entre proporciones para variables cualitativas y la prueba de diferencia entre medias para variables cuantitativas, estableciendo siempre, a priori, el nivel de rechazo de la hipótesis nula (α ou p).
Componentes de las medidas de bioseguridad: bioseguridad conceptual, bioseguridad operacional y bioseguridad estructural.
Bioseguridad conceptual: se refiere a las medidas de prevención o control contra peligros presentes en el entorno para delimitar las medidas relacionadas con el cerco y portón sanitario.
Bioseguridad estructural: se refiere a medidas de prevención o control contra peligros presentes en las instalaciones, objetos, utensilios, cama, plagas, etc.
Bioseguridad operacional: se refiere a medidas de higiene para el personal interno, visitantes, personal subcontratado y fijo.
Principios de bioseguridad en


Los cambios tecnológicos y climáticos son constantes y escuchamos hablar de ello todo el tiempo. Desde los países del hemisferio norte llegaron noticias de calor extremo, sequías e incendios forestales a causa de esto.
Cómo preparar nuestras estructuras y ajustar la gestión para mitigar las consecuencias y efectos del estrés calórico que pueden sufrir las aves es el tema de este artículo.
¿Cuáles serían las influencias de estos cambios climáticos, altas amplitudes de temperatura y humedad, a menudo diarias según las estaciones, y las correlaciones con el manejo de la alimentación, el consumo de agua, el estrés por calor, la ventilación y el confort ambiental de las aves?
Las líneas genéticas de aves de corral se seleccionan para un desempeño zootécnico cada vez más eficiente y productivo, pero requieren mejores condiciones y confort térmico en los galpones.

Las altas temperaturas también interfieren en el desempeño y en la fase de producción, incluso con una menor generación de calor que un pollo de engorde (Foto 1)


Sin embargo, bajo estrés por calor, las aves dirigirán la energía a la pérdida de calor corporal y nutrientes importantes ya no se absorben ni se utilizan para la producción de huevos, lo que resulta en una caída en la productividad, fertilidad y eclosión de las aves (Figuras 1 y 2)
El agua es el ingrediente principal de la dieta diaria y su consumo puede modificarse a medida que aumenta la temperatura ambiente. Este consumo muchas veces puede duplicarse o triplicarse (Figura 3).
Una de las formas más efectivas para que las aves pierdan calor es aumentar su frecuencia respiratoria, lo que hace que el sistema respiratorio ayude con la pérdida de calor corporal. Sin embargo, para mantener el equilibrio, las aves beben más agua.
Véase un trabajo con pollos de engorde, adaptado por Cobb, que muestra el ratio de consumo de agua en pollos de engorde según las diferentes temperaturas de manipulación (Figuras 4 y 5).
El desempeño de los pollos de engorde en galpones con ambiente más controlado, con ventilación tipo túnel, más aislamiento con doble cortina, sistemas de enfriamiento eficientes, entre otras mejoras, deberían ser mejores siempre y cuando la gestión esté bien hecha y los controles sean efectivos (Figura 6).
Y otra lista que muestra la importancia de este ingrediente y su dependencia y respuesta en el comportamiento de consumo de las aves.

Y por supuesto, minimizan los efectos del calor y del aumento de la temperatura exterior. Este es un hallazgo constante y cada vez más común en construcciones nuevas, cada vez mejores galpones con material aislante en el revestimiento.
El aislamiento térmico del revestimiento con diferentes métodos es fundamental para el correcto funcionamiento de los gallineros, lo que minimiza la ganancia de calor en verano y la pérdida de calor en invierno (Foto 2).
Existen varios tipos de materiales utilizados para el aislamiento térmico en galpones, como revestimientos plásticos, plástico con aluminio, celulosa y materiales más novedosos, como fibra de vidrio y lana de roca, poliuretano, poliestireno expandido, entre otros, (Foto 3).
Forro de cortina en galpones.
La principal fuente de calor en un galpón son las propias aves.
Cuanto más grande es el ave, mayor es la producción de calor. Un pollo produce alrededor de cinco BTU de calor por hora por cada libra de peso vivo. Así, un ave de 2.700 gramos produce 30 BTU de calor por hora. Si consideramos un galpón con 20.000 aves, tenemos un total de 600.000 BTU por hora.



Forro en pollos de engorde.
La capacidad aislante de diferentes tipos de materiales se mide según un coeficiente de intercambio térmico entre superficies, el valor R; cuanto mayor sea el valor R, mayores serán las propiedades aislantes del material.
El calor del techo es la segunda fuente de calor en los galpones. Los estudios demuestran que los tejados metálicos o las tejas de fibrocemento pueden irradiar un calor de 65 a 70°C (Foto 4).

Y esto sólo considerando la producción de calor sensible (calor por conducción, radiación y convección). Si consideramos el estrés por calor, las aves pueden perder el doble de esta cantidad por evaporación de agua a través del sistema respiratorio.

En muchas regiones, los galpones para aves son bastante sencillos y antiguos. En estos casos se recurre a plantar árboles o instalar mamparas para dar sombra a los laterales. Estas simples medidas pueden proporcionar mejores condiciones ambientales para las aves, (Foto 5)
El mejor mecanismo sensible de pérdida de calor para las aves es la convección, y esto se logra mediante el uso de ventiladores y extractores de aire en las granjas.

En nuestra concepción, los galpones deben tener velocidades para intercambiar el aire del interior al exterior de unos 37 segundos, es decir, si tienen entre 150 y 200 metros de largo, deben tener un viento de 4 a 5 metros por segundo de aire y velocidad por las campanas. Los galpones convencionales, por el contrario, deben tener un ventilador para al menos 50 a 60 metros cuadrados del galpón.
Usamos sistemas de enfriamiento para ayudar a reducir la temperatura del aire que ingresa a los galpones. Es el caso de las placas evaporativas, mucho más eficientes por esta capacidad.
Los nebulizadores también son equipos muy eficientes. Sin embargo, su uso debe hacerse con mucho cuidado y se deben considerar los siguientes consejos:
Los sistemas de refrigeración por agua sólo deben utilizarse después de temperaturas superiores a 27,5°C como mínimo. Lo ideal es por encima de los 28°C;
Para aves de primera y segunda semana, polluelos en regiones cálidas, cuando las temperaturas superan los 36°C podemos utilizar placas o nebulizadores. Pero solo después de usar una velocidad del aire de aproximadamente 0,5 a 1 m/s con los ventiladores, intente primero la convección y luego el enfriamiento adiabático con evaporación de agua.
Recuerde siempre que no queremos poner demasiado viento encima de las aves, así que utilice la placa o el nebulizador sólo durante unos segundos, unos 15 a 30 segundos;
Para aves de edades intermedias, tercera y cuarta semana, donde el se desarrolla deformación, se aplica el mismo criterio de girar las placas sólo después de aproximadamente 1,5 m/s de velocidad del viento y durante un tiempo de 30 a 45 segundos;
Para aves adultas con plumas en la quinta, sexta y séptima semana, los sistemas de enfriamiento solo deben estar por encima de los 2,8 metros por segundo de velocidad del aire, casi cualquier sistema de escape o ventiladores encendidos, y pueden usar las placas y los nebulizadores (siempre la placa primero, luego los nebulizadores). Podemos utilizar un tiempo de encendido de 1 a 2 minutos y un tiempo de apagado de 2 a 5 minutos para que las placas no se sequen del todo. A esta gestión la llamamos empapado y remoje de las placas durante su uso.
¿Estamos preparando las granjas para los efectos del aumento de temperaturas y el calor extremo?
DESCARGUE EN PDF
Referencias consultadas: previa consulta con los autores.



El continente americano definido geográficamente por los países de Canadá y Argentina, incluyendo el amplio grupo de islas que se encuentran en el océano atlántico, ha mantenido flujos migratorios permanentes por múltiples razones:
Dentro de este inmenso espectro geográfico se encuentran combinaciones multiculturales, enriquecidas por conocimientos y experiencias interesantes, favoreciendo la creatividad y la innovación.
Este detalle estimula una constructiva competencia: gana-gana, entre el personal y la dirección de las compañías.
Algunas conocidas corporaciones laboran simulando la lava de un volcán que se encuentra activo. Al observarse el cráter se aprecia que este denso material se mantiene en permanente ebullición: la creatividad e innovación que en cualquier momento es expulsada.
Eduardo Cervantes López, Consultoría Internacional Gerencia Productiva e Innovadora en Procesamiento de Aves, Barranquilla, Colombia.El complemento contradictorio es el comportamiento del recurso humano en lo que concierne a la “humildad” que se puede enmarcar dentro de estos tres segmentos: Básico, Optativo y Autoritario: “Aquí y Ahora”.
En este continente existen países que tienen regulaciones laborales claras y de estricto cumplimiento que el personal acata disciplinadamente. A pesar de ello, el flujo de personas hacia ellos es muy dinámico. Este hecho se denomina Básico
De igual forma, en muchas empresas prestan sus servicios connotados funcionarios que se han distinguido por sus logros alcanzados, proyectándose como modelos inspiradores a seguir. Este plus ejerce un efecto contagioso de motivación productiva. Este nuevo escenario se llama Optativo
Es un estado mental crítico. Quienes lo padecen se obsesionan con una serie de conceptos expresados por personas conocedoras del tema sobre el procesamiento de las aves que al analizarlos se detectan preocupantes incoherencias conceptuales.
La literatura actualizada existente física – libros, revistas, etc. –y digitalmente despeja las dudas que obviamente surgen.
Mientras tanto, el resto del personal administrativo que trabaja en la planta prefiere guardar una actitud prudente por respeto a la jerarquía del funcionario que tiene la ceguera gerencial.
Por último, existe otro grupo de organizaciones donde sus directores son muy exigentes. Esta característica restringe a muchos de sus colaboradores a intercambiar ideas sobre las actividades que ejecutan.
Consecuencias: se disminuye significativamente la participación del personal. En casos críticos quienes pertenecen a estas compañías se limitan a realizar estrictamente el trabajo asignado. Este comportamiento representa un alto riesgo, porque sus comunicaciones son incompletas, incongruentes y no expresadas en tiempo real. Consecuencia: ¡Se dificulta obtener la Excelencia Operacional!
A medida que pasa el tiempo esta situación alcanza niveles caóticos por el aumento de los reclamos y devoluciones de los clientes, afectando los resultados económicos de la empresa.
Ante este ambiente de ambigüedad conceptual, la dirección de la empresa decide contratar reconocidos expertos para que estudien la problemática, hagan las recomendaciones y se constaten los resultados en tiempo real.

Normalizada la calidad y el rendimiento de los pollos procesados, se hacen los comentarios pertinentes para que, en un futuro, cuando se detecten situaciones que afectan los parámetros de gestión y por ende la calidad de los productos procesados, se definan las acciones a seguir que permitan poner en orden el desarrollo del faenamiento diario. En algunos casos estas enseñanzas se tienen en cuenta como filosofía empresarial. ¡En otros desafortunadamente no!
En muchas plantas en Latinoamérica se procesan dos tipos de pollos: Blancos a los cuales se les ha retirado la epidermis. Amarillos que la conservan. La faenadora objeto de estudio saca al mercado ambos pollos.
Los aspectos medulares de esta actividad se deben monitorear en tiempo real.
En caso de presentarse alguna situación que comience a alterar la Calidad Grado A y los Rendimientos establecidos por la dirección general de la compañía, debe corregirse a la mayor brevedad posible para minimizar las pérdidas que se ocasionan.
A continuación, se definen los detalles más importantes que deben supervisarse en cada una de las distintas actividades secuenciales que se realizan diariamente.
Panel de enfriamiento evaporativo de PVC

• Panel de plástico con alta eficiencia de enfriamiento
• Disponible en el rango de altura 1200, 1500, 1800, 2000 y espesor 150
• Alta capacidad de oscurecimiento
Para mayor ilustración se presenta este ejemplo real. pericoli.com
PLAScool HE DARKCuando es insuficiente – menor de 8 horas-, las aves durante el desangrado sorpresivamente comienzan a aletear intensamente, se levantan perpendicularmente y se dejan caer libremente.
Consecuencias: maltrato en ambos lados de las alas originándose dislocaciones a nivel de la articulación de la clavícula - hueso de la suerte- y el húmero. Punto de Control para determinar la causa: Salida de la última desplumadora. El buche no debe observarse. Sólo cuando contiene alimento, sobre sale este órgano.
Determinada esta condición se debe notificar al área de producción avícola para que hagan la respectiva investigación y tomen las acciones correctivas correspondientes de inmediato.
En la planta, al haber detectado el origen de esta anormalidad, evitar tomar decisiones inexplicables y costosas, ya que el encargado de la sección de aturdido equivocadamente decide aumentar la corriente, para tranquilizarlos.
Esta mayor cantidad de amperaje, a pesar de que los pollos están saliendo del aturdidor y/o completamente inconscientes, afecta la eficiencia en el desangrado y desplumado por la mayor contracción muscular que se ocasiona.
En éste, todos los ganchos deben tener pollos. Esta condición sine qua non debe cumplirse estrictamente.
Inexplicablemente en algunas plantas deciden procesar pollos, colocando un pollo dejando el siguiente gancho vacío, para disminuir la velocidad de proceso a la mitad. Matemáticamente es correcto.

Sin embargo, durante el procesamiento se causan un conjunto de afectaciones en la calidad y el rendimiento de los pollos procesados
 Foto 1. Todos los ganchos deben tener pollos para evitar afectaciones en la calidad y rendimiento de estos.
Foto 1. Todos los ganchos deben tener pollos para evitar afectaciones en la calidad y rendimiento de estos.
Como se mencionó anteriormente, todos los ganchos deben estar llenos. No cumplir este requerimiento técnico deteriora la calidad y el rendimiento porque el exceso de corriente que reciben los pollos que están dentro de la tina, ocasiona un exceso de corriente correspondiente a los ganchos desocupados. Este tipo de aturdido utiliza sistema en paralelo.
Detalle puntual: el nivel del agua de la tina debe llegar hasta las ¾ partes de la longitud del pescuezo, nunca debe tocar la pechuga. Si ocurre puede ocasionar dislocaciones de la articulación del hombro originándose hemorragias.
El tiempo debe establecerse dependiendo de la ubicación de la planta y condiciones ambientales. Alturas superiores a 1.200 metros y climas fríos, demanda aumentar la evacuación de la sangre en un rango que oscila entre los 3 y 3,5 minutos.
Superarlo puede anticipar el proceso de rigor mortis o endurecimiento muscular.
Si esto se produce, las condiciones normales de escaldado y desplumado deben ajustarse.
Esta decisión tiene efectos negativos en la calidad y el rendimiento de los pollos.
Esta etapa debe mantener un adecuado equilibrio entre estas variables:

Tiempo.
Temperatura.
Turbulencia del agua.
Inversión completa de las aves a lo largo del recorrido.
Si los pollos han recibido un exceso de corriente y el tiempo de desangre es excesivo, los músculos estarán más endurecidos.

Por lo tanto, las plumas de las alas y la cola que son las únicas insertadas en ellos demandarán una mayor presión para ser removidas.
 Foto 2. El nivel del agua de la tina debe llegar hasta las ¾ partes de la longitud del pescuezo.
Foto 2. El nivel del agua de la tina debe llegar hasta las ¾ partes de la longitud del pescuezo.
Es esencial proteger la calidad durante el aturdimiento, sacrificio, escaldado y desplumado. Cualquier daño al producto generará pérdidas costosas y de rendimiento. BAADER ofrece equipos altamente ajustables que se adaptan al tamaño del pollo y a las prácticas locales. Contamos con todo lo necesario para ofrecerle una línea de sacrificio y desplumado donde se obtendrán productos uniformes y de alta calidad.

Para obtener más información, comuníquese con la oficina de ventas local de BAADER o llame al +45 86 23 14 55.

La planta visitada no cumplía cabalmente con “todos” estos detalles técnicos, relacionados. Cuando ingresaban a las desplumadoras, al no tener compañeros a su lado, se movían como si estuvieran dentro de una lavadora, donde la ropa gira para un lado y luego para el otro. Los daños en la uniformidad de la epidermis y las dislocaciones en las alas eran enormes.
Como el nivel del agua cubría unos 3 centímetros la parte superior de la pechuga que es donde está la mayor cantidad de carne. Durante el despresado y/o deshuesado, se encontraron hemorragias de todo tamaño en esta región del pollo que tiene la mayor demanda en el mercado.




Comunicaciones Inconsistentes y Ceguera
Gerencial: ¿Cómo afectan la calidad y el rendimiento de los pollos procesados?


DESCÁRGALO EN PDF

 Desplumado de pollos.
Foto 4. En el desplumado evitar dislocaciones en las alas.
Desplumado de pollos.
Foto 4. En el desplumado evitar dislocaciones en las alas.



En Chore-Time, vamos hasta el n del mundo para atender a nuestros clientes. Eso signi ca que trabajamos arduamente para ofrecerles el sistema avícola adecuado. Signi ca que ofrecemos soluciones innovadoras para sus retos especí cos. Y signi ca que tenemos literalmente una presencia física cerca para apoyarle... esté donde esté en el mundo.


Obtenga más información en choretime.com





Chore-Time es una división de CTB, Inc. Una Compañía de Berkshire Hathaway





Héctor
M. Cervantes1 y Larry R. McDougald21Departamento de Salud Poblacional, Facultad de Medicina Veterinaria, Universidad de Georgia, Athens, Georgia, EE.UU.
2Departamento de Ciencias Avícolas, Facultad de Agricultura y Ciencias del Medio Ambiente, Universidad de Georgia, Athens, Georgia, EE.UU.

La industria avícola ha estado utilizando los mismos agentes anticoccidianos para la prevención de la coccidiosis durante varias décadas. La última aprobación de un agente anticoccidiano nuevo fue en Estados Unidos por la Administración de Drogas y Alimentos (FDA) en 1999 con el diclazuril y actualmente ninguna compañía de salud animal está trabajando activamente en el desarrollo de anticoccidianos nuevos.

Además, en Estados Unidos, los anticoccidianos de la clase de los ionóforos se consideran antibióticos y, por lo tanto, no se pueden usar en la producción de pollos o pavos producidos sin antibióticos, como los que llevan las etiquetas “Nunca Antibióticos” (NAE) o “Producidos Sin Antibióticos” (RWA).
La producción de aves criadas sin antibióticos se ha disparado en los últimos años debido a:

La preocupación por la posible transferencia de resistencia a los antibióticos de los productos avícolas a los consumidores.
La presión incesante de los grupos activistas.
Las preferencias de los consumidores. Las campañas de mercadeo.
Esto ha puesto a la industria avícola en una posición difícil, ya que la prevención de la coccidiosis debe lograrse solamente mediante el uso de anticoccidianos sintetizados químicamente, los llamados “químicos” y las vacunas vivas.
Aunque existen algunas excepciones como la nicarbazina que se ha utilizado con éxito todos los años durante la época de invierno desde 1955. Los anticoccidianos sintetizados químicamente son más propensos al desarrollo de resistencia, y cuando esto ocurre, el control de la coccidiosis se torna más difícil.
Además, el buen control de la coccidiosis es un factor importante para prevenir la Enteritis Necrótica (EN) causada por el Clostridium perfringens Esta enfermedad ha surgido como una de las más importantes en las aves producidas sin antibióticos.

Esto se puede deber al desarrollo de resistencia a los anticoccidianos químicos, a la falta de efecto antibiótico de estos y a la imposibilidad de usar antibióticos con buena actividad anticlostridiana.



Por otra parte, el uso de las vacunas vivas para prevenir la coccidiosis también se ha incrementado significativamente en los últimos años, paralelamente al incremento en la producción de aves criadas sin antibióticos.


Aunque las vacunas vivas son efectivas cuando se administran correctamente, las coccidias vacunales tienen que multiplicarse varias veces en los intestinos para generar buena inmunidad.
Como resultado de estas multiplicaciones, se producen lesiones intestinales leves que además generan una respuesta inflamatoria que produce un exceso de moco intestinal, y este sirve de substrato para la multiplicación exagerada de cepas patógenas de Clostridium perfringens.
Estas no pueden controlarse mediante el uso de antibióticos en las aves producidas sin antibióticos, dando como resultado final la aparición de brotes de EN.
Por lo tanto, es muy probable que el uso de las vacunas vivas también haya desempeñado un papel en la aparición de la EN como la enfermedad más importante en las aves producidas sin antibióticos.
Con el objeto de predecir la efectividad de los agentes anticoccidianos en el campo, se han desarrollado y utilizado Pruebas de Sensibilidad Anticoccidiana, AST, de sus siglas en Inglés.
Estas pruebas pueden ser muy útiles cuando se realizan e interpretan correctamente. Con las tendencias actuales en la producción avícola, las pruebas de AST son una de las herramientas más valiosas a disposición de los productores para lograr con éxito el control de la coccidiosis a largo plazo.
Una AST es una prueba de laboratorio en la que coccidias aisladas a partir de muestras de campo (generalmente, excretas o cama) de diferentes granjas de un complejo de producción, se analizan bajo condiciones controladas para determinar su sensibilidad a varios agentes anticoccidianos con el fin de predecir su eficacia en el campo.
Para optimizar la selección de los agentes anticoccidianos en el campo, es fundamental conocer el perfil de sensibilidad de los parásitos en cuestión.
La AST es el mejor método actualmente disponible para evaluar y predecir la eficacia de los agentes anticoccidianos contra aislamientos de campo de Eimeria spp. en la producción comercial de pollos y pavos de engorda.
Varios investigadores y veterinarios de campo han enfatizado la importancia de realizar las pruebas de AST para la detección temprana de resistencia o “sensibilidad reducida” a las coccidias antes de que la productividad de la parvada se vea afectada negativamente.
Las AST también se utilizan para determinar la eficacia anticoccidiana en estudios de aprobación de agentes anticoccidianos nuevos.
Las AST son un predictor útil de la eficacia anticoccidiana cuando los aislamientos de campo de Eimeria spp. son representativos de los existentes en un complejo de producción comercial.
También son útiles para detectar cambios tempranos en la sensibilidad a los agentes anticoccidianos.

Cada día, el mundo pide a los productores avícolas que consigan más. Más crecimiento. Más eficiencia. Y cada día, tienes que enfrentarte a más y mayores retos que superar. Hay muchos productos en el mercado que prometen grandes mejoras, pero no cumplen esas promesas. Ahora puedes confiar en NOVUS y en sus soluciones de nutrición inteligente que te aportan mucho más. NOVUS pone a tu alcance una tecnología avanzada, basada en estudios científicos y diseñada para ayudar a tus aves a alcanzar todo su potencial. Juntos, podemos mostrar al mundo que puedes conseguir mucho más.


porcentuales en las puntuaciones de las lesiones entre los controles tratados y negativos y positivos es el parámetro más importante para detectar cambios en la sensibilidad.
de cada anticoccidiano antes de iniciar la prueba para comprobar que los anticoccidianos se hayan adicionado y mezclado correctamente.
Por lo tanto, aunque la ganancia de peso corporal, la tasa de conversión alimenticia y la viabilidad se registran por su importancia económica, en este artículo, el porcentaje de reducción en las puntuaciones de lesiones será el parámetro utilizado para evaluar la sensibilidad de las coccidias a partir de aislamientos de campo.
Una parte muy importante de un AST es la recolección y envío de muestras al laboratorio. Esto es importante para preservar la viabilidad de los ooquistes presentes en la muestra y para que esta sea verdaderamente representativa de las Eimeria spp. presentes en el complejo de producción de donde se recolectaron las muestras. Dado que no es posible, ni necesario, muestrear todas las granjas en un complejo de producción, será suficiente una obtener muestras de entre 5 y 10 granjas.


Como afirma H. D. Chapman “es probable que los resultados de una granja sean similares a los de otras granjas dentro del mismo complejo de producción, siempre que se haya empleado el mismo programa de quimioprofilaxis para prevenir la coccidiosis”.


Las muestras de excretas o cama se deben recolectar de al menos 6 lugares dentro de la sección de crianza del galpón siguiendo un patrón en zigzag.
Si se recolecta cama, esta debe recolectarse del tercio superior de la cama y en cantidad suficiente para llenar un contenedor de un galón.
Si se recolectan excretas, deben recolectarse al menos 24 excretas frescas, incluyendo tanto excretas intestinales, como cecales.
Para aumentar la probabilidad de recuperar suficientes ooquistes para preparar los inóculos desde el primer pase, se deben recolectar muestras de parvadas que tengan entre 21 y 28 días de edad que es cuando la excreción de ooquistes es mayor.
Las muestras deben enviarse al laboratorio a donde se llevarán a cabo las AST en una hielera bien sellada por correo de entrega urgente al día siguiente, y se deben adicionar algunas bolsas de hielo para evitar que las muestras se sobrecalienten durante el transporte. Se debe evitar que las muestras se sobrecalienten, pero no permitir que se congelen, ya que tanto el calor como el frío en exceso son perjudiciales para la supervivencia de los ooquistes.

El primer día de la prueba, los pollitos se reciben de la incubadora y se distribuyen al azar en corrales de piso libres de coccidias con cama nueva de viruta de madera. Se alimentan con una ración de iniciación estándar libre de agentes anticoccidianos hasta el día 12.

Descargue la guíao

¿Qué tipo de niple es mejor para sus animales?
El día 12, los pollos se distribuyen aleatoriamente a cada jaula (generalmente 8/jaula) y se cambian a sus respectivas raciones experimentales.
Por lo general, hay de 3 a 5 repeticiones/tratamiento.
Los pollos asignados a los controles negativo y positivo continúan recibiendo una ración no medicada, Mientras que los pollos tratados son alimentados con raciones que contienen los anticoccidianos en las concentraciones dietéticas que se probarán en cada tratamiento.
El día 14, todos los pollos, excepto el control negativo, se inoculan con el inóculo preparado previamente a partir de las muestras de excretas o cama titulado para que contenga aproximadamente 1 x 105 ooquistes esporulados de Eimeria spp/ml.
El inóculo se administra por sonda oral con una jeringa graduada.
En el caso de los pollos, el inóculo suele contener una mezcla de Eimeria acervulina, E. maxima y/o E. tenella.
También el día 14, se pesan todos los pollos por jaula y se calcula el peso promedio por pollo y se registra como el peso inicial.
En este momento, también se registra la cantidad de alimento administrado a cada jaula para calcular el índice de conversión alimenticia al final de la prueba.
El día 20 (6 días post-inoculación), todos los pollos de cada jaula se pesan de nuevo para calcular el aumento promedio de peso corporal.

También el día 20, se pesa el alimento restante para calcular el índice de conversión alimenticia para cada tratamiento.

Ese mismo día, los pollos se sacrifican humanitariamente para extirpar los tractos intestinales y calificar la severidad de las lesiones intestinales inducidas por el desafío con coccidias por el método de Johnson y Reid.

Basado en el manuscrito de L.R. McDougald, si los puntajes de lesión para cualquier región dada del tracto intestinal (superior, medio, inferior o ciego) se reducen en 50% o más, las coccidias se consideran sensibles al anticoccidiano respectivo.
Mientras, si las puntuaciones de las lesiones se reducen entre 49% y 30%, las coccidias se consideran de sensibilidad intermedia al anticoccidiano respectivo.
En tanto, si las puntuaciones de las lesiones se reducen en 29% o menos, las coccidias se consideran resistentes al anticoccidiano respectivo.
A pesar de que un AST solo dura 20 días, las muestras primero deben remitirse al laboratorio y pasarse en pollitos libres de coccidias para preparar el inóculo (en ocasiones, se requiere de un segundo pase para obtener la concentración de ooquistes deseada).


Después, los pollitos deben ordenarse con anticipación, las raciones experimentales tienen que mezclarse y analizarse.
Finalmente, los resultados deben tabularse para remitir un reporte final, de modo que esperar resultados antes de 8 semanas, y más probablemente 10 semanas, no es realista.
Además, idealmente, se debe realizar un estudio preliminar de titulación de dosis con las coccidias aisladas para determinar la dosis que producirá suficientes lesiones macroscópicas y depresión del crecimiento sin mortalidad (esto aumentará aún más el tiempo en el que se podrá obtener el reporte final).
El mayor beneficio de realizar las pruebas de AST se deriva de analizar muestras de un complejo de producción al menos una vez al año.
Con el tiempo, se pueden generar y utilizar evaluaciones razonables de la eficacia o grado de resistencia presente en el complejo de producción, con el objetivo de diseñar programas de quimioprofilaxis más efectivos.

De igual manera, por consistencia, es mejor usar el mismo laboratorio para las pruebas de AST.
También es importante enviar muestras representativas, asegurándose de que no estén expuestas a la luz solar directa, al calor o al frío excesivos y que se envíen por correo urgente para favorecer la supervivencia de los ooquistes.
Recuerde que tener que realizar un segundo pase no es deseable, ya que la proporción de especies de Eimeria en la muestra original puede alterarse y dar un resultado erróneo de la sensibilidad.
Los formularios de envío deben completarse en su totalidad, indicando el historial previo de uso de anticoccidianos y detallando qué
A medida que la industria avícola produce un mayor porcentaje de aves sin antibióticos y anticoccidianos de la clase de los ionóforos, y depende más de los anticoccidianos sintetizados químicamente, las pruebas de sensibilidad a los anticoccidianos (AST) pueden proporcionar una herramienta muy valiosa para diseñar programas más efectivos para la prevención y el control de la coccidiosis.
Mantener la eficacia de los agentes anticoccidianos para prevenir la coccidiosis es importante para minimizar la incidencia de Enteritis Necrótica, que se ha convertido en la enfermedad más importante en las aves criadas sin antibióticos.

*Referencias bibliográficas bajo consulta al autor.
Nota: “Derivado de un trabajo presentado en la LXX reunion de la Western Poultry Disease Conference”.
DESCÁRGALO EN PDF
Cómo obtener el máximo beneficio de una Prueba de Sensibilidad Anticoccidiana (AST)1Encargado de la Planta de incubación, Las Camelias
2Universidad Nacional de Entre Ríos, Argentina
SPIDES, Short Periods of Incubation during Eggs Storage, (Períodos cortos de incubación durante el almacenamiento de huevos) es una práctica aplicable para reducir pérdidas de nacimientos en huevos cargados con muchos días de almacenamiento.


El trabajo que se resume en este articulo se llevó a cabo en diversas pruebas en una planta de incubación en Argentina entre 2014 y 2019, donde para validar el método se realizó el tratamiento en una incubadora de etapa única con una carga de 124.416 huevos, y se efectuó otra carga sin tratamiento como testigo con la misma carga, 248.832 huevos en total.

Esta investigación se desarrolló en la empresa Las Camelias, Planta de Incubación Liebig, localizada en Liebig, municipio del distrito Segundo del departamento Colón, en la provincia de Entre Ríos, República Argentina.
 Fernando Aguet1 e Ing. Andrea Dribin2
Fernando Aguet1 e Ing. Andrea Dribin2
Como ejemplo, mostramos una prueba realizada en Octubre. El tratamiento SPIDES se aplicó a 124.416 huevos, en una incubadora de etapa única, en la cual seguirá luego el proceso de incubación.


Al momento de comenzar el tratamiento el huevo tenia entre 5 y 6 días de almacenamiento (fechas 17/10 y 18/10).
El 23/10 se realizó un calentamiento hasta 75°F por 1 hora y luego 4 horas más hasta que la temperatura de la máquina llega a 97,5°F y posteriormente se comienza a enfriar (Gráfico 1).
Gráfico 1.- Carga en la incubadora con el primer calentamiento térmico y posterior enfriamiento.
La carga permanece en la incubadora a 65°F hasta el día 28/10, cuando se realiza un segundo tratamiento térmico (Gráfico 2) donde permanece:
Desde las 6 hrs hasta las 8 hrs a temperaturas entre 75 y 90°F;
Desde las 8 hrs hasta las 11 hrs a temperatura por encima de 90°F;
Desde las 11 hrs hasta las 18:30 hrs a temperatura entre 90° y 75°F;
Permaneciendo 48 horas más en frío; y Comenzando la incubación a la madrugada del 31/10.
Gráfico 2.- Carga en la incubadora con el segundo calentamiento térmico y posterior enfriamiento.

Los lotes que se tomaron para la prueba son:
Lote 296 - 33 semanas
Lote 297 - 32 semanas
Lote 298 - 29 semanas
Como testigo se incubaron los mismos lotes (Gráfico 3) con igual cantidad de días de almacenamiento (13 y 14 días) en otra incubadora de etapa única con el mismo programa, pero sin el tratamiento SPIDES.
Además, se colocaron data loggers en los carros (Gráfico 4) para registrar también temperatura de huevo.
Gráfico 4.- Monitoreo y registro de datos en tiempo real de la temperatura.
Gráfico 3.- Comportamiento del Lote 296
El Gráfico 5 a lo largo de los 26 días (7 de tratamiento + 19 de Incubación) se ve de la siguiente manera:
1 ciclo de calor seguido por 4 días de frío, luego otro ciclo de calor seguido por 2 días de frío y posteriormente arranca el ciclo normal de incubación.
Gráfico 5.- Muestra durante 26 días (7 de tratamiento + 19 de Incubación).
Asimismo, se utilizó un programa de 20 etapas (Gráfico 6), para la etapa de calor de SPIDES se utiliza agua caliente y resistencias para tener un calentamiento más homogéneo.
Para enfriar se abre el dámper en el primer momento para lograr un enfriamiento rápido.

Una vez que la temperatura de la máquina es inferior a la temperatura de la sala, se cierra el dámper para mantener los 65ºF en la incubadora.

El éxito de su planta de incubación depende por completo de la cantidad y la calidad de los pollitos que puede producir y de la eficiencia de sus operaciones. En Petersime, lo entendemos perfectamente y sabemos lo que necesita para dirigir un negocio de éxito.
Ofrecemos incubadoras reconocidas mundialmente y soluciones completas para plantas de incubación, combinadas con soporte 24/7 y toda nuestra experiencia. Esto garantiza que obtendrá el mayor beneficio económico de sus plantas de incubación, no solo ahora, sino también durante toda su vida útil. Ofrecemos el mayor beneficio de por vida.


Al día de la transferencia se comparó el % de embriones inyectados con una vacunadora in ovo que nos indica la cantidad de embriones viables (Gráfico 7).
La máquina vacunadora elimina los “claros”: infértiles y embriones con mortandad embrionaria temprana.

Evidentemente hubo un beneficio del tratamiento SPIDES con mayor numero de embriones vivos a la transferencia.
Gráfico 7.-El porcentaje de embriones vacunados in ovo indica la cantidad de embriones viables.

En función de los huevos fértiles que obtuvimos calculamos el rendimiento (Gráfico 8) como % de Nac/Fértiles y como % de nacimientos (Gráfico 9).
Gráfico 8.-Rendimiento obtenido de porcentaje de nacimientos sobre huevos fértiles


Gráfico 9.-Valores obtenidos de % de nacimiento sobre el total de huevo incubado.
Este trabajo demostró que el sistema SPIDES funciona, solo hay que disponer de máquinas extra para este fin, luego de este estudio en esta planta se trataron más de 25 millones de huevos entre enero de 2014 a enero de 2019, con buenos resultados y consistentes a través de todos los lotes.
Experiencia en uso de SPIDES en incubadoras de etapa única
DESCÁRGALO EN PDF

Alicia Dal Santo, Vanessa Forcellini, Ana Paula Gonzatti, Lucas Zanella, Gustavo S. Hoepfner, Eduarda da Silva, Milena P. Marin, Bruna B. Caus, Fernanda Danieli A. Valentini, Heloisa Pagnussatt, Lilian K. Girardini y Tiago Goulart Petrolli
Universidad del Oeste de Santa Catarina, Brasil.
Como cualquier producto de origen animal, los huevos son perecederos y la pérdida de calidad es inevitable. Diversos factores, individualmente o en conjunto, pueden influir en la calidad del huevo. Entre ellos, edad y genética de la reproductora, temperatura, humedad, dieta y contaminación.

Después de la oviposición, la vida útil y la calidad están relacionadas con procesos externos, por lo que es necesario tomar medidas preventivas, desde la recolección en la granja hasta la comercialización.
Actualmente, la vida útil máxima autorizada por la inspección es de 30 días, un tiempo corto en comparación con otros productos de origen animal.
Ante esto, es necesario desarrollar nuevas tecnologías que mitiguen los impactos negativos del almacenamiento prolongado de huevos.
Para ello, se enfoca en procesos que reducen el biofilm y la carga microbiana en la parte externa de la cáscara, adicionado a procesos para sellar sus poros externos, impidiendo el intercambio de gases y la migración de humedad entre el ambiente interno y externo de los huevos.
El cloro es efectivo contra muchos microorganismos y no es tóxico en las concentraciones recomendadas, teniendo una rápida acción bactericida en solución acuosa, formando ácido hipocloroso (HOCl), que puede penetrar en la célula bacteriana y liberar oxígeno, oxidando los componentes esenciales del protoplasma, provocando la muerte celular. (GREZZI, 2007).
Las enzimas, a su vez, son proteínas que digieren los componentes orgánicos presentes en la cáscara, facilitando su limpieza.
Aun así, el uso de aceites esenciales es cada vez más frecuente en la producción animal debido principalmente a sus propiedades antimicrobianas.
Esto es posible porque los aceites tienen moléculas hidrofóbicas que pasan libremente a través de la pared celular y la membrana citoplasmática bacteriana, causando pérdida de iones y daño a las estructuras internas de la célula, resultando en su muerte, y pueden tener un efecto desinfectante en la parte externa de la cáscara del huevo (Pesavento et al. al. 2015).
Además de los desinfectantes, para sellar los poros también se utilizan componentes de sellado, por ejemplo, ceras, goma laca.
La goma laca es un polímero natural refinado a partir de la secreción de Kerria lacca, se encuentra en forma de escamas o polvo insípido, tiene varias finalidades.

El objetivo fue evaluar si la aplicación de tres protocolos de tratamiento para la limpieza y/o sellado de los poros de la cáscara influye en la calidad de la misma, verificando si existe efecto de agregar diferentes protocolos de limpieza y/o sellado de la cáscara, en 45 días de almacenamiento, sobre la calidad física y microbiológica de los huevos, para brindar información y técnicas que puedan contribuir a la evolución de la cadena productiva.
El experimento fue realizado en el sector avícola del Núcleo de Ciencias e Investigaciones Aplicadas en Monogástricos (NUPAM) de la Universidad del Oeste de Santa Catarina - Xanxerê.
Se utilizaron un total de 480 huevos de color comerciales, provenientes de gallinas ponedoras de la estirpe Hy-Line brown, clasificados en clasificadora automática, en la clasificación tipo “grande”, con un peso promedio de 57g ± 2,5g, según resolución n .1/2003. (Brasil, 2003).
Todos los huevos utilizados fueron frescos, dispuestos en un diseño experimental completamente al azar en arreglo factorial, que constó de cuatro tratamientos y dos periodos de almacenamiento (Tabla 1)
Tratamiento
Control negativo (sin higienización)

Tiempo de almacenamiento
45 días
Lavado con Cloro 45 días
Lavado con Mezcla de Enzimas + Cloro
Lavado con cloro + Aceites esenciales + Goma Laca
45 días
45 días
La aplicación se realizó por aspersión manual, así: tratamiento con cloro – 50ppms y limpieza física; mezcla enzimática – mezcla al 0,4% de concentración con posterior lavado con cloro a 50ppm y limpieza física; Tratamiento de lavado con cloro a 50ppms + aplicación de aceites esenciales + goma laca, con un tiempo de acción de 30 segundos, con posterior limpieza física, además de un tratamiento de control negativo.
Los huevos se almacenaron a temperatura ambiente, en bandejas de celulosa, y se mantuvieron almacenados durante 45 días.
Todos los huevos se pesaron en una balanza de precisión, luego se rompieron en una mesa de vidrio especial y se sometieron inmediatamente a evaluaciones de calidad de cáscara, albúmina y yema.
Se pesaron individualmente huevos enteros, cáscara y yema, y el peso de la albúmina se obtuvo por la diferencia entre el peso del huevo entero y la suma de los pesos de cáscara y yema.
Tabla 1. Tratamientos utilizados.La altura de la albúmina se midió con un altímetro especial (Egg Quality Micrometer) y el peso se obtuvo con una balanza de precisión.

Para la calidad de la albúmina se utilizó la Unidad Haugh, siguiendo la metodología propuesta por Card y Nesheim (1968) calculada según la ecuación:
UH= 100 log (H + 7,57 - 1,7W
Donde UH = unidad Haugh; H = altura de la albúmina (en milímetros); W = peso del huevo (en gramos).
Para el conteo bacteriano se utilizó una adaptación de la metodología descrita por MOTTA et al., (2007).
El inóculo inicial se preparó con mezclas de huevos homogeneizados en bolsas de Stomacher.
Asimismo, se realizaron diluciones seriadas de hasta 10-6 en microtubos que contenían 900ul de solución salina y 100ul de inóculo.
La altura de la yema se midió con un altímetro, con un valor obtenido en milímetros, y el diámetro de la yema con un paquímetro digital, también en milímetros.
La calidad de la yema se evaluó mediante la obtención del índice de yema, que consiste en la relación entre la altura de yema y el diámetro de yema, según la fórmula: IG = altura de yema (mm)/diámetro de yema (mm).
Para evaluar la calidad de la cáscara se utilizó un texturómetro (LY-TX-700, Tecnal, Piracicaba, Brasil), que evalúa la resistencia de la cáscara a la rotura, con resultados expresados en kgf.
Posteriormente, los huevos fueron quebrados para obtener el peso de la cáscara, pesada en una balanza de precisión.
Posteriormente, se realizó el recuento en placa Agar PCA, por duplicado.
Después de la incubación (37°C/48h), se contaron las colonias y se calculó el número de unidades formadoras de colonias por mililitro (UFC mL-1) de las muestras, multiplicando el número de colonias contadas en las placas por el inverso de la dilución en que se realizó el conteo. Los resultados experimentales se sometieron a la prueba de normalidad de Shapiro Wilk, seguida de análisis de varianza. En caso de diferencia significativa, los datos experimentales se compararon con la prueba de Tukey al 0,05 de probabilidad, utilizando el software estadístico R.
En la Tabla 2 se representan los parámetros cuantitativos de los huevos almacenados por 45 días, los cuales no mostraron diferencia (P>0,05) entre el control negativo y las demás alternativas evaluadas.
*Medias seguidas de letras diferentes en la misma línea difieren estadísticamente a través de la Prueba de Tukey, al 0,05 de significación. Neg – Control Negativo. GL- Goma Laca.
En la Tabla 3 se muestran los resultados cualitativos evaluados entre los diferentes tratamientos, en los que se puede observar una diferencia significativa (P>0,05) en los huevos sometidos a lavado con cloro, que presentaron medias superiores para la altura de clara de huevo (3,04 mm), unidad Haugh (46,30 mm) y resistencia de cáscara (4,57 kgf).
*Medias seguidas de letras diferentes en la misma línea difieren estadísticamente a través de la Prueba de Tukey, al 0,05 de significación. Neg – Control Negativo. GL- Goma Laca.
 Tabla 2. Parámetros cuantitativos de huevos almacenados por un período de 45 días sometidos a diferentes tipos de higienización.
Tabla 3. Parámetros cualitativos de los huevos almacenados por un período de 45 días.
Tabla 2. Parámetros cuantitativos de huevos almacenados por un período de 45 días sometidos a diferentes tipos de higienización.
Tabla 3. Parámetros cualitativos de los huevos almacenados por un período de 45 días.


En la Tabla 4 se comenta la evaluación microbiológica de los huevos almacenados, cuyos huevos pertenecientes al control negativo y lavados con cloro presentaron conteos bacterianos más bajos (P<0,05). El tratamiento de lavado con Blend de enzimas + cloro fue el que presentó mayor conteo bacteriano (P>0,05), siendo considerado el menos eficiente.
Tabla 4. Conteo bacteriano de huevos almacenados por un período de 45 días.

*Medias seguidas de letras diferentes en la misma línea difieren estadísticamente a través de la Prueba de Tukey, al 0,05 de significación. Neg – Control Negativo. GL- Goma Laca.
Oliveira et al (2020) evaluaron el uso de pectina como recubrimiento para mantener la calidad de huevos refrigerados y no refrigerados por 5 semanas, y a partir de la 3 semana en adelante se observó pérdida de peso en huevos sin recubrimiento, indicando que el recubrimiento logra la capacidad para sellar la cáscara, evitar la entrada de contaminación y pérdida de fluidos.
A los 45 días de almacenamiento se observó mayor altura de clara y mayor unidad de haugh para los huevos lavados con cloro y con la mezcla de enzimas + cloro.
Estos resultados pueden explicarse por la capacidad del cloro para formar ácido hipocloroso (HOCl) cuando se agrega al agua y promover la acción bactericida rápidamente, penetrando en la célula y liberando oxígeno, que oxida los componentes esenciales del protoplasma bacteriano, provocando la muerte celular bacteriana (GREZZI, 2007), resultando en menor número de contaminantes.
Panini (2019) utilizó agua clorada para evaluar los efectos en comparación con los huevos no desinfectados en la calidad e higiene de la cáscara.
No encontró diferencia significativa entre tratamientos en cuanto al análisis de unidad de Haugh, índice de yema, pH y pérdida de peso del huevo a diferentes temperaturas y periodos de almacenamiento
Sin embargo, concluyó que la temperatura fue un factor determinante para la conservación de los huevos, especialmente los sometidos a refrigeración que obtuvieron pérdida de peso retardada en comparación con el tratamiento que permaneció a temperatura ambiente.

Hubo mayor resistencia de la cáscara de los huevos sometidos al lavado con cloro y con cloro + Aceites esenciales + Goma Laca, en comparación con los demás tratamientos, esto se debe a que el principal objetivo de la utilización de recubrimientos es:
Promover una película protectora para los huevos y consecuentemente se reducirán los problemas de contaminación microbiana, minimizando las pérdidas de agua y dióxido de carbono.
Mejorando las propiedades de permeabilidad de la cáscara, se reduce la degradación interna, lo que permitirá mayores tiempos de almacenamiento y aumentará la resistencia de la cáscara a los impactos, manteniendo las características y propiedades nutricionales. (BRASIL et al.2019).
Oliveira et al (2020), sin embargo, no observaron diferencias significativas en el uso de recubrimiento a base de pectina sobre la unidad Haugh (HU), cuando se almacenaron en refrigeración, en contraste cuando los huevos recubiertos a temperatura ambiente mostraron los mejores resultados y parámetros de calidad en el periodo evaluado.
Song et al (2022), investigaron los efectos de emulsiones biobasadas de goma laca (S) inducidas por la incorporación de aceite esencial de aguja de pino (PNEO), con efectos en las propiedades físicas, funcionales y antibacterianas de recubrimientos en la conservación de huevos.
Los resultados mostraron óptima estabilidad de aplicación y almacenamiento, excelente desempeño de barrera contra el vapor de agua, oxígeno, barrera ultravioleta y efecto bacteriostático del recubrimiento que contribuyó al empaque de los huevos.
El proceso de contaminación del huevo y su gravedad están totalmente relacionados con la presencia de suciedad adherida a la cáscara y a la carga microbiana inicial. El propósito de la higienización es reducir o eliminar las poblaciones bacterianas en la superficie y, en consecuencia, en el interior.
No obstante, es fundamental una preselección visual de los huevos, para eliminar aquellos con algo de suciedad de la línea de higienización, optimizando la acción de los sanitizantes a base de cloro. (NETO et al 2019).

En el presente estudio, los huevos pertenecientes al tratamiento que recibió lavado solo con cloro, presentaron mejor calidad microbiológica, con menor conteo bacteriano total.

Diferentes metodologías de tratamiento de la cáscara de huevo: Impactos sobre la calidad física y microbiológica de huevos comerciales DESCÁRGALO EN PDF
resistencia de la cáscara está relacionada con el tiempo de almacenamiento y su capacidad para sellar y evitar la entrada de microorganismos para mantener las características de calidad. La acción bactericida del cloro favorece una menor carga microbiana y un menor deterioro en la cáscara, promoviendo una mayor calidad y resistencia.
Neto et al (2019), en el uso de diferentes procedimientos y sanitizantes, también observaron eficiencia en el procedimiento de lavado con cloro 100 ppm en la eliminación del grupo de coliformes totales, donde se obtuvo una frecuencia de eliminación del 100% en tres repeticiones frente a la coliformes totales.
Mientras, Panini (2019) usó agua clorada y evaluó sus efectos en comparación con huevos no desinfectados y concluyó que microbiológicamente todos los tratamientos fueron efectivos para reducir la contaminación microbiana de la cáscara del huevo, sin diferencia significativa entre ellos.
El lavado con cloro presentó el mejor conjunto de eficiencia, tanto en la mantención de la calidad de la albúmina como en la resistencia de la cáscara, siendo la mejor herramienta para ser utilizada en los programas de higienización de huevos. El lavado de huevos influye positivamente en la aceptación del producto por parte del consumidor, ya que mejora la apariencia para su comercialización.
Estableciendo el estándar en la producción de huevos

• Estableciendo el estándar en la producción de huevos

• Calidad de los huevos que cuenta





• Resultados robustos
• Persistencia superior en la puesta de huevos
• Generando dinero para su negocio
• Éxito en todo el mundo



1Prestage Department Poultry Science, North Carolina State University, Raleigh, NC, USA
2DSM firmenich, Getzersdorf, Austria
3DSM-firmenich, Getzersdorf, Austria
La evaluación de micotoxinas es frecuente en las fábricas de alimentos balanceados para fuentes de cereales como maíz, trigo y cebada o productos como maní y semillas de algodón.
Sin embargo, la harina de soja, la fuente de proteína más común en los alimentos balanceados para todas las especies animales, necesita más atención en este aspecto crítico de la calidad.

harina de soja parece ser menos susceptible a la contaminación por micotoxinas que la mayoría de los cereales.
No obstante, se pueden observar diferencias significativas en la contaminación con micotoxinas entre las fuentes de harina de soja.
 Edgar O. Oviedo Rondón1 , Anneliese Mueller2 and Bettina Behler-Wöchtl3
Edgar O. Oviedo Rondón1 , Anneliese Mueller2 and Bettina Behler-Wöchtl3
Reportes previos han indicado que las principales micotoxinas eventualmente observadas en las harinas de soja pueden ser:
Fumonisinas (FUM)

Zearalenona (ZEN)
Deoxinivalenol (DON)
Aflatoxinas (Afla) Ocratoxinas (OTA)
Sin embargo, varias publicaciones sugieren cierta variabilidad por región. Ese efecto debe aclararse para determinar si la contaminación se relaciona con:
El lugar donde se recolectaron las muestras; o
El origen de la producción y gestionar los riesgos de acuerdo con estos factores.
Tricotecenos (T2).
Las evaluaciones globales de las muestras son necesarias ya que las harinas de soja tienen un comercio considerable en todo el mundo. Se han reportado diferencias relevantes en la calidad de los nutrientes y el procesamiento entre los países de origen.
Los datos presentados aquí también indican diferencias entre las fuentes de harina de soja en cuanto a la contaminación por micotoxinas.
Los datos sobre los niveles de micotoxinas en la harina de soja que se presentan en este artículo forman parte del World Mycotoxin Survey de dsm-firmenich.
A partir de 2004, es el conjunto de datos más completo y de mayor duración sobre la aparición de micotoxinas y permite estudiar la variación en la aparición de micotoxinas en todo el mundo.
Dsm-firmenich ofrece análisis de micotoxinas a los clientes como un servicio para identificar el riesgo de micotoxinas en sus commodities de materias primas y alimentos finales.
El incremento del tamaño de la muestra a lo largo de los años brinda un conocimiento detallado sobre la incidencia de las seis principales micotoxinas en los productos agrícolas utilizados para la alimentación de los animales.
Esta información ayuda a identificar los riesgos potenciales que se plantean para la producción animal por región o en los ingredientes importados para alimentos balanceados.


La mayoría de los resultados incluidos en el levantamiento se obtienen utilizando métodos como ELISA, HPLC o métodos de múltiples micotoxinas basados en LC-MS/MS de última generación.




Las muestras que dieron positivo a una de las principales micotoxinas, también se presentan como porcentaje de muestras contaminadas.
El promedio y la mediana de los positivos se calculan en ppb de todas las muestras analizadas positivamente. También se describen los niveles máximos.
Rara vez se observan niveles tan altos, pero aun así ocurren y marcan la importancia de realizar pruebas para detectar la presencia de micotoxinas.
China, Estados Unidos, Brasil, Argentina e India son los principales productores de harina de soja. Los 27 países de la Unión Europea pueden producir más harina de soja juntos que la India, pero no como países individuales.






Los resultados de este estudio se resumen en la siguiente Tabla y la prevalencia de cada micotoxina por país en las Figuras.
Los niveles de contaminación de todas las muestras de soja a nivel mundial son siempre inferiores que los reportados en los granos, confirmando lo que han indicado los artículos científicos.

Sin embargo, están presentes en este alimento y ocasionalmente pueden contribuir a la contaminación total del alimento balanceado.

Es evidente las diferencias entre los países productores de harina de soja sobre los tipos de micotoxinas y los niveles de contaminación
India.
La variabilidad en el número de muestras por país corresponde a todas las muestras recibidas de cada origen para el tamizaje de micotoxinas este año.
Las micotoxinas observadas con mayor frecuencia fueron ZEN, FUM y DON.
Estas indicaron que la contaminación con mohos Fusarium es la más común en las harinas de soja en todo el mundo.


En China (Figura 1), Argentina (Figura 4) e India (Figura 5), 86% u 82% de las muestras fueron positivas para ZEN; sin embargo, en India, el 97% de las muestras analizadas fueron positivas para OTA y el 92% positivas para T2 (Figura 5). La harina de soja Estadounidense (Figura 2) tuvo el porcentaje más bajo de muestras positivas para ZEN (28%) entre los cinco países estudiados y la concentración promedio y mediana más baja (17 y 15 ppb) o el nivel máximo (38 ppb) de ZEN.
En todos los demás países, los niveles de ZEN observados fueron casi tres veces más altos (2,3 a 3,6). Los niveles más altos de ZEN (Tabla 1) se observaron en muestras de Argentina y Brasil (1000 y 809 ppb).




Las aflatoxinas fueron la segunda micotoxina más común observada en las harinas de soja Argentinas, siendo positivas el 63% de las 1.459 muestras evaluadas (919 muestras).


Sin embargo, los niveles de contaminación rondaron las 2-3 ppb en la soja Argentina observaron niveles similares en las harinas de soja China e India, con 29% y 26% de las muestras positivas para Afla.

Muy pocas muestras de Brasil (13 de 673) y Estados Unidos (2 de 43) tenían Afla (Figuras 3 y 2).
No obstante, la concentración mediana de Afla en las muestras brasileñas fue de 4 ppb. En comparación, las dos muestras de EE.UU. alcanzaron una media de 45 ppb, lo que podría considerarse valores atípicos y difíciles de volver a observar.
Ninguna muestra de harina de soja brasileña fue positiva para OTA (Figura 3), indicando una contaminación baja o nula con mohos Penicillium en estas muestras.






No se observó T2 en las muestras chinas (Figura 1), pero el 46% (26 de 56) fueron positivas para DON.

(Figuras 1 y 2) y concentraciones medianas similares (Tabla 1).

De acuerdo a la concentración mediana de estas micotoxinas y el número de muestras positivas en el levantamiento realizado, la harina de soja de Estados Unidos es actualmente la fuente más segura para evitar la contaminación por múltiples micotoxinas.

Sin embargo, siempre es aconsejable monitorear las micotoxinas en todas las harinas soja cada año porque pueden ocurrir concentraciones de micotoxinas debido a las fluctuaciones climáticas anuales
En la última edición abordamos cómo el transporte y el tiempo de espera afectan la viabilidad de los pollitos.
Uno de los argumentos para reducir los tiempos de espera y transporte permitidos se basa en la suposición de que el embrión del pollo de engorde moderno produce más calor y que su “índice metabólico más alto” tiene posibilidad de utilizar la yema residual después del nacimiento con más rapidez que en el pasado. Aunque es una teoría atractiva, los datos publicados no la respaldan.


Aviagen conserva líneas de control genético, que fueron separadas de sus poblaciones pedigree respectivas en 1972. En un ensayo realizado en 2017, se compararon las líneas de control genético con sus equivalentes actuales.
La tasa a la que se utilizó la yema residual fue muy similar entre las líneas de control y sus contrapartes modernas. Cuando esperan 72 horas después de la cosecha de los pollitos, las líneas analizadas utilizaron solo un poco más del 80% de la yema residual presente en el nacimiento.

La Figura 3 muestra que la tasa de utilización fue ligeramente superior en la línea de control de 1972 que en su equivalente moderno a las 24 horas, y fue igual a las 48 y 72 horas.
Utilización de la yema residual después de 72 horas, pollitos no alimentados
Tratamiento del frío
85,0 °F | 29,4 °C
80,0 °F | 26,7 °C
75,0 °F | 23,9 °C
Línea de control 1972
La temperatura ambiental es importante durante el transporte y almacenamiento de los pollitos y durante el transporte en las cajas.
Es importante diferenciar entre la temperatura del aire de la sala, la temperatura
alrededor del pollito y la temperatura corporal del pollito. La velocidad a la que circula el aire alrededor del pollito también marcará una gran diferencia en la temperatura que siente. (Figura 4).
Temperatura en la caja
Objetivo de temperatura en la caja
Cuando los pollitos nacen, no tienen un control total de su temperatura corporal, sino que esta cambia con la temperatura del aire que los rodea.
Sin embargo, los pollitos sí generan calor metabólico, y tienen la capacidad de modificar su comportamiento si tienen demasiado frío, acurrucándose, o si tienen demasiado calor, aumentando la distancia entre pollitos y jadeando (Figura 5).
La temperatura corporal de los pollitos de un día de vida puede medirse con facilidad, de forma segura y precisa, utilizando un termómetro pediátrico Braun ThermoScan® en la cloaca.
Cuando hay pequeños grupos de pollitos no alimentados en cajas para transporte, la temperatura objetivo de la cloaca de 39,4°C-40,6°C (103°F-105°F) se alcanzará, por lo general, si la temperatura en el interior de la caja es de alrededor de los 30°C (86°F).
En ensayos internos donde la temperatura ambiental de las cajas se aumentaba o disminuía en 6°C (11°F), a 24°C (75°F) o 36°C (97°F), también cambiaban las temperaturas corporales de los pollitos.
Figura 5. Adaptación del comportamiento a las temperaturas fuera de la zona de confort de un pollito. (de izquierda a derecha) Los pollitos con frío se acurrucan y los pollitos con calor jadean, mientras que los pollitos que se sienten cómodos se dispersan y se relajan.





Los pollitos en el entorno más cálido subían 0,4°C (0,7°F).
Los pollitos en el entorno más fresco bajaban 0,4°C (0,7°F) de temperatura corporal en las primeras 24 horas.

Sin embargo, después de 48 horas de espera, la temperatura corporal de los pollitos en los ambientes cálidos y óptimos permaneció estable, mientras que los pollitos en el ambiente más frío tuvieron una disminución de temperatura más pronunciada de 3,1°C (5,6°F).
El cambio en la temperatura de la cloaca con el tiempo, promediado a lo largo de tres ensayos, se muestra en la Figura 6.
Cambios en la temperatura de la cloaca en un tiempo de espera de 72 horas
106 °F (41,1 °C)
Temperatura de la cloaca
104 °F (40,0 °C)
102 °F (38,9 °C)
100 °F (37,8 °C)
98 °F (36,7 °C)
96 °F (35,6 °C)
94 °F (34,4 °C)
92 °F (33,3 °C)
0 24 48 72 96
Horas desde la cosecha de pollitos
Frío - 75,2 °F (24 °C) Óptimo - 86,0 °F (30 °C)
Alta 96,8 °F (36 °C)
La temperatura de espera no tuvo un gran efecto en la velocidad a la que los pollitos utilizaban la yema residual.
Sin embargo, una pequeña cantidad de aves en el tratamiento con frío dejaron de movilizar la yema después de 48 horas de espera. Esto hizo que la utilización de la yema a las 60 horas pareciera menor que la de los pollitos de control que se encontraban en un ambiente óptimo.
Algunos informes de la bibliografía señalan que los extremos de temperatura después del nacimiento pueden retrasar o detener la utilización de la yema.
La Figura 7 muestra la utilización de la yema en un período de 72 horas, promediada en tres ensayos.
Yema residual utilizada después de 72 horas, pollitos no alimentados

Frío - 75,2 °F (24 °C)
Óptimo - 86,0 °F (30 °C)
Alta 96,8 °F (36 °C)
0 24 48 60
Horas desde la cosecha de pollitos
Frio - 75,2 °F (24 °C) Ideal - 86,0 °F (30 °C)
Quente - 96,8 °F (36 °C)
La viabilidad hasta los 7 días fue diferente en cada ensayo, pero los efectos del tratamiento fueron muy similares.
En la Figura 8, las tasas de mortalidad para el tratamiento de control en cada ensayo se trataron como una línea de base unitaria, y la diferencia debido a la temperatura adversa se calculó como un incremento relativo.
Las poblaciones que permanecieron en el ambiente frío perdieron 2,7 veces la cantidad de pollitos que tenían las poblaciones que se mantuvieron a una temperatura cómoda. El ambiente cálido también incrementó las pérdidas, pero el aumento fue de solo 1,5 veces.
Mortalidad relativa a los 7 días después de una espera de 72 horas a distintas temperaturas de espera (tratamiento óptimo = 1)
Aunque el transporte en un ambiente demasiado fresco es más duro para los pollitos que el transporte en un ambiente demasiado cálido, también es mucho menos probable que se produzca enfriamiento en el transporte.
Los pollitos producen calor metabólico y, al colocarse juntos en cajas, la meta es impedir que se acumule demasiado calor. No obstante, los ensayos dejaron un mensaje muy claro de que, en los esfuerzos para evitar el calor excesivo, es de vital importancia no excederse.

Consulte la tercera parte de este artículo en la próxima edición.
Factores que afectan el confort y la viabilidad de los pollitos, desde la nacedora hasta el galpón de crianza – Parte II DESCÁRGALO EN PDF
Figura 8. Mortalidad a la primera semana promediada a lo largo de 3 ensayos y expresada como un múltiplo de la mortalidad del tratamiento de temperatura óptima.
20 POLLITOS MÁS POR HEMBRA

PUNTOS MEJOR EN CONVERSIÓN ALIMENTICIA 2
MÁS RENDIMIENTO



ALIMENTO POR POLLITO -10,5% +0,4% +0,6%

VIABILIDAD +0,6%










MEJOR DESEMPEÑO DEL MERCADO MENOR COSTO EN TODA LA CADENA PRODUCTIVA








PECHUGA PIERNAS




La salud intestinal es vital para la salud, bienestar y rendimiento de las aves.
Al lograr una óptima salud intestinal, se garantiza una adecuada absorción de nutrientes, lo que a su vez se traduce en un crecimiento y productividad eficientes. Además, contribuye al fortalecimiento del sistema inmunológico de las aves, brindándoles una mayor protección frente a trastornos y enfermedades intestinales.
MV Cecilia Rodríguez Redactora Técnica Vetanco Argentinaque pueden afectar la salud intestinal. Tras el nacimiento, el intestino comienza a colonizarse con microorganismos del entorno, los cuales van conformando un ecosistema microbiano diverso y dinámico.
El equilibrio de la microbiota intestinal es un factor importante para prevenir trastornos y enfermedades.

Esta comunidad de microorganismos desempeñan un rol fundamental en:
El desarrollo y fortalecimiento del sistema inmunológico.
Además de proporcionar una protección de la mucosa intestinal contra agentes nocivos.
adecuado en la microbiota intestinal resulta de vital importancia para asegurar la salud y el bienestar de las aves.
Además, la preservación de la integridad intestinal se convierte en un aspecto esencial para alcanzar una óptima salud intestinal.
A lo largo del ciclo productivo, múltiples factores relacionados con la alimentación, el ambiente, las condiciones sanitarias, entre otros, pueden afectar significativamente la integridad intestinal.
La interacción de la microbiota con la mucosa intestinal abre nuevas perspectivas para el diseño de estrategias que promuevan la salud intestinal y optimicen el rendimiento productivo en la industria avícola.

El enfoque en una óptima salud intestinal es fundamental para alcanzar una producción avícola sostenible, en compromiso con el medio ambiente y la salud pública.
La adopción de medidas que reduzcan la necesidad del uso de antibióticos contribuye significativamente a enfrentar el desafío mundial actual de la resistencia antimicrobiana, además de mantener un ecosistema más equilibrado y garantizar la producción de alimentos más seguros para los consumidores.

Esta herramienta digital ha sido diseñada para:
En respuesta a esta creciente necesidad, surge el programa “Antibiotic Free”, una iniciativa integral y holística que une todas las opciones naturales desarrolladas por Vetanco y BV Science.

Su enfoque se basa en el control y prevención de agentes nocivos, con el objetivo de mantener la salud intestinal y hepática de las aves.
El programa se complementa con la implementación de estrategias de bioseguridad rigurosas, las cuales contribuyen a enfrentar los riesgos sanitarios actuales presentes en la producción avícola, minimizando la entrada y propagación de patógenos y reduciendo el potencial de enfermedades.
Para lograr este propósito, es crucial contar con medidas y herramientas precisas que permitan monitorear y evaluar el estado de la calidad intestinal y hepática de manera efectiva.
En el marco del compromiso continuo con la salud y bienestar animal, VETANCO ha desarrollado la innovadora aplicación APP VIIP – Vetanco Intestinal Integrity Program, con el objetivo de brindar un soporte técnico único y diferencial sobre la línea de productos que forman parte de este nuevo programa “Antibiotic Free”.
Los problemas que afectan la calidad intestinal de las aves de forma eficiente y precisa.
Al contar con una evaluación objetiva de la calidad intestinal y la identificación temprana de problemas, es posible implementar estrategias de manejo que reduzcan la necesidad de antibióticos y promuevan un enfoque más preventivo y responsable en la sanidad avícola.
 MEDIR
MEDIR
La APP VIIP es una herramienta valiosa y eficaz para mejorar la salud intestinal en la industria avícola, lo que podría tener un impacto positivo en la productividad, el bienestar y la sostenibilidad de la producción avícola.
La APP VIIP permite un seguimiento detallado durante necropsias periódicas, facilitando a profesionales veterinarios y técnicos el registro sencillo de datos y mediciones de interés clave en sus dispositivos móviles.
Con la posibilidad de geolocalizar las granjas y adjuntar imágenes, se logra un análisis más completo.
Los datos recopilados incluyen observaciones y mediciones macroscópicas y microscópicas, que son puntuadas bajo criterios establecidos para lesiones en distintos órganos del sistema digestivo de las aves. Estos datos se procesan mediante complejas fórmulas matemáticas para generar resultados significativos.


La información recopilada se almacena en una interfaz web segura y de fácil acceso, lo que permite realizar análisis retrospectivos y aplicar diversos filtros para comparar y examinar en detalle los resultados obtenidos.
La capacidad de sectorizar y profundizar en la información proporciona una visión completa de la salud intestinal en las granjas avícolas.
De esta manera, se obtiene una evaluación objetiva del estado de la calidad intestinal y se identifican los índices de riesgo, que permiten detectar las problemáticas como disbiosis y coccidiosis, ya sea clínica o subclínica.

Contar con información objetiva, ordenada y digitalizada, es fundamental para tomar acciones correctivas y decisiones fundamentadas en tiempo real.
Este enfoque basado en datos científicos y técnicos permite implementar un manejo más efectivo y personalizado, anticipándose a los problemas antes de que se extiendan y mejorando así el bienestar y rendimiento de las aves.
El análisis de los datos recopilados es un punto importante para identificar rápidamente tendencias, lo que permite, no solo aplicar acciones correctivas, sino también evaluar la efectividad de las mismas. De esta manera, podemos ajustar estrategias y mejorar los procesos para optimizar la producción avícola.
La APP VIIP – Vetanco
Intestinal Integrity Program representa un avance significativo en el monitoreo y evaluación de la calidad intestinal en aves.

Al facilitar el registro y análisis en tiempo real, así como el acceso a una interfaz web para análisis retrospectivos, esta innovadora herramienta proporciona una solución integral para la detección temprana de problemas intestinales y la toma de decisiones precisas y oportunas en el ámbito de la producción avícola.
Optimizando la salud intestinal avícola con la innovadora App VIIPVetanco Intestinal Integrity Program DESCÁRGALO EN PDF

AFI en Filipinas se especializa en soluciones clave a la mano para la industria avícola. El propietario de AFI, Hugh McDougall, explica que MagFan es el número uno y que, con el nuevo Solectrifier de DACS, están experimentando un auge en su negocio.

Hugh McDougall: En este clima, los ventiladores a menudo se agotan durante el día, a temperaturas ambiente altas y también con una presión estática bastante alta. La mayoría de los ventiladores convencionales simplemente no pueden hacer frente a eso.
Pero los MagFans, parece que pueden funcionar para siempre y siempre tienen una reserva de energía porque así es como DACS los diseñó.
“Simplemente, podemos aumentar la velocidad del ventilador, si alguna vez lo necesitamos, y ofrecen un rendimiento masivo y constante a una fracción del costo de funcionamiento”.
Cuando se trata de ahorro de energía, ¡nosotros predicamos! No podemos permitirnos el lujo de solo hablar de Transición Verde. ¡Debemos actuar! La energía no solo es costosa, sino que la red eléctrica pública también está bastante sobrecargada y es frágil, por lo que un alto consumo de energía puede provocar fácilmente fallas en el suministro eléctrico.

Los MagFans suelen generar ahorros asombrosos del 60 al 70% en comparación con los ventiladores convencionales.
Eso en sí mismo significa un menor consumo de energía y, en consecuencia, un grado mucho mayor de estabilidad del suministro y, por supuesto, una factura de energía mucho más baja.
“Además, los ventiladores toleran un rango de voltaje mucho más amplio que los ventiladores convencionales, y eso es de suma importancia en un país donde el suministro de 230 V fluctúa entre 160 y 270 V”.
El MagFan es el ventilador de mayor eficiencia energética que encontrará. MagFan se ha desarrollado utilizando el diseño CFD más avanzado combinado con pruebas de prototipos a gran escala en una de las instalaciones de pruebas más avanzadas de Europa.
En una comparación directa con los principales proveedores del mercado actual, MagFan ofrece al menos un 50% menos de consumo de energía con caudales equivalentes. Lea todo sobre esto aquí.
AFI estuvo entre los primeros distribuidores de DACS en probar el nuevo Solectrifier y Hugh ve muchas oportunidades con este nuevo producto:
El Solectrifier es una forma completamente nueva de pensar en la energía solar. Alimenta de energía solar directamente al ventilador, sin pérdidas de conversión y sin inversor separado.

Durante el día, los MagFans pueden funcionar con energía solar pura, sin consumo de energía de la red. Es un verdadero sistema de energía dual. La combinación de energía solar y de red está completamente automatizada.
asegurando un suministro de energía óptimo para los ventiladores.
No solo ahorra mucha energía. El Solectrifier también alivia la red y ayuda a mantener una buena calidad de energía sin fluctuaciones de voltaje y con la seguridad adicional de un sistema de energía dual.
“Este es un gran activo también cuando se trata del bienestar animal y la protección de la inversión de nuestros clientes”, concluye Hugh.
El Solectrifier evita automáticamente utilizar energía de la red, manteniendo la energía solar como fuente de energía primaria pero siempre
El Solectrifier recolecta electricidad directamente de los paneles fotovoltaicos y alimenta esta electricidad a través del MagDrive directamente al MagFan, lo que reduce el consumo de electricidad hasta en un 91%.

La tecnología Solectrifier permite que los MagFans funcionen completamente fuera de la red durante el día, cuando los paneles fotovoltaicos proporcionan la energía necesaria para impulsar los ventiladores.

DACS A/S es una empresa familiar que produce y vende sistemas de ventilación y control climático. Nuestra sede está en Dinamarca y llevamos orgullosamente sirviendo a la empresa durante más de 35 años.
Somos conocidos por un enfoque práctico, artesanos altamente calificados y un conocimiento sustancial sobre el control del clima. DACS tiene una red global de distribuidores y opera en más de 50 países.
Ofrecemos sistemas de control de ventilación y clima que mejoran enormemente el bienestar y la comodidad de los animales, lo que permite que los animales prosperen y crezcan a su máximo potencial.
Al mismo tiempo, los costos de gas y electricidad se reducen al mínimo. Factores clave que rentabilizan su producción y fortalecen su competitividad.
Todos nuestros sistemas están diseñados para brindarle la mejor eficiencia energética sin comprometer el clima y el bienestar animal.
Nuestros sistemas reducirán su costo total de funcionamiento en un 40% en comparación con otros sistemas y aun así garantizamos condiciones climáticas óptimas que permiten que sus aves utilicen todo su potencial genético.

Productos de primer nivel con eficiencia y durabilidad extrema.
Productos y sistemas desarrollados por expertos en ventilación.
Perfecta climatización gracias a la extraordinaria distribución del aire.
Servicio personalizado de artesanos y técnicos calificados.
Visite https://dacs.dk/ para obtener más información
MagFan es el número uno en nuestro negocio DESCÁRGALO EN PDF

Luis Abarca-Blanco1 y Otávio Antônio Rech2
1Veterinario avícola en Trouw Nutrition Latam
2Nutricionista avícola en Trouw Nutrition Latam
La integridad intestinal juega un papel crítico en la producción animal. Ha ganado interés debido a la búsqueda de rentabilidad, la preocupación por el bienestar animal y la necesidad de reducir el uso de antibióticos.

Una adecuada integridad intestinal asegura el aprovechamiento de nutrientes y mantiene el equilibrio en la microbiota para lograr un buen desarrollo y producción. También minimiza el porcentaje de huevo sucio y reduce el impacto ambiental del amoníaco y otros gases que afectan el bienestar de las aves.
En Europa, las enteritis bacterianas son las responsables del 50 a 70% del uso de antibióticos. Además, muchos de estos problemas se presentan de manera subclínica, por lo que no son detectados, generando un alto impacto económico.
El mantenimiento de la integridad intestinal va mucho más allá de la adición de un promotor de crecimiento en la dieta y debe ser evaluado de manera integral.
Los desafíos para las aves comienzan con su llegada a la granja, un ambiente totalmente nuevo en el que deben adaptarse rápidamente.

Luego, durante el periodo entre la segunda y décima semana, las aves enfrentan despiques, desafíos sanitarios, procesos de vacunación incluyendo vacunas vivas de IBD, ND, IBV entre otras, que replicarán en el tracto gastrointestinal (TGI) y que también aportan su cuota.

Posteriormente, se produce el traslado y su adaptación a nuevas condiciones de manejo, además de cambios hormonales que generan inmunosupresión a medida que se alcanza el pico de producción.

Otros factores como los apagones, problemas con el equipo de alimentación, la calidad de agua, fondos de silo, depredadores, robos y cualquier otro que genere estrés también deben tenerse en cuenta.
Los eventos más frecuentes a nivel intestinal ocurren como resultado de un desequilibrio en la microbiota, donde algunas bacterias aprovechan el exceso de nutrientes o cambios en las condiciones incrementando sus poblaciones.
Este es el caso de la disbiosis o disbacteriosis (Foto 1) donde no hay una bacteria específica responsable y por ende un aislamiento o antibiograma no resulta de utilidad. Se caracteriza por signos inespecíficos como diarrea, presencia de gas, inflamación, etc., lo que disminuye los rendimientos y predispone a problemas más severos.
Desde el punto de vista nutricional, se ha asociado con dietas desequilibradas, de baja digestibilidad, soyas mal cocidas, harinas de carne y pescado de mala calidad, grasas rancias, etc.
Disbacteriosis: presencia de gas y descamación celular. Cortesía Dra. Lucy García.

La enteritis necrótica es causada por Clostridium perfringens, un habitante normal del intestino, que produce toxinas que generan necrosis de la mucosa, pseudomembranas (Foto 2) y alta mortalidad.
La integridad intestinal se comienza a formar desde la postura del huevo, que debe contener todos los nutrientes y anticuerpos necesarios para el adecuado desarrollo del ave. Las aves que sufren sobrecalentamiento en el último tercio de la incubación nacen con un intestino más corto.




La duodenitis necrótica focal es asociada con Clostridium colinum y aunque rara vez causa mortalidad, provoca pérdidas en producción y rendimientos. Sus signos clínicos son inespecíficos y muchas veces difíciles de identificar. Se caracteriza por la presencia de úlceras en el duodeno que se observan durante la necropsia (Foto 3).
Además, el rápido consumo de agua y alimento desarrollan mejor las vellosidades y las glándulas accesorias multiplican su tamaño en los primeros 10 días. Por lo tanto, un adecuado manejo resulta indispensable. La microbiota intestinal se estabiliza alrededor del día 21, por lo que la calidad microbiológica de agua y alimento serán trascendentales.
Es indispensable un estricto control sobre las materias primas, regulando el uso de ciertos ingredientes.
Se debe evaluar el nivel de micotoxinas, analizar posibles sinergias, implementar un adecuado programa de conservación de materia prima, utilizar secuestrantes de buena calidad que ayuden a controlar las toxinas, así como sus efectos en el ave.
En general, no debemos perder de vista que las afecciones intestinales suelen ser problemas multifactoriales que requieren un abordaje integral.
Foto 2. Diferentes grados de evolución de una enteritis necrótica asociada a E. tenella. Foto 3. Duodenitis necrótica focal. Cortersía de Trouw NutritionTambién revisar la calidad de las grasas, la cocción de la soya, la digestibilidad y calidad de las materias primas en general. El uso de nutrición de precisión y la mayor cantidad de fases posible permitirán ajustar la dieta a las necesidades fisiológicas del ave, evitando un exceso de nutrientes en las partes bajas del intestino.

Técnicas como el “Split Feeding” incluso ajustan los nutrientes de acuerdo con las necesidades de la ponedora en diferentes momentos del día. Otros factores como una adecuada granulometría, adecuados niveles de grasa y proteína y la adición de enzimas exógenas puede ayudar a promover la salud intestinal.
El agua de bebida debe ser potable, con un pH ácido, ya que el agua básica reduce la actividad de las enzimas digestivas, favorece la producción de biopelículas y endotoxinas debido a la proliferación de algas y microbios.


Los ayunos prolongados deben ser evitados pues alteran el pH y la motilidad intestinal. Después de cinco horas de ayuno, los caracteres de la mucosa cambian y aumenta la enteritis mucoide.
Durante mucho tiempo se han utilizado antibióticos como promotores de crecimiento para evitar desequilibrios y controlar principalmente al C. perfringens.
Sin embargo, existen pocas opciones disponibles que llevan más de 40 años en el mercado y han generado mucha resistencia.
Se han buscado alternativas, como el uso de ácidos orgánicos de cadena corta y media
Estos funcionan mediante dos mecanismos: en primer lugar, reducen el pH del medio generando un ambiente hostil para bacterias patógenas como C. perfringens, Salmonella spp.,




También se ha demostrado que estas sustancias tienen sinergias en diversas combinaciones, por lo que se han desarrollado diferentes presentaciones, como ácidos libres, buferados o protegidos, cada uno con diferentes propiedades y enfoques para controlar diferentes zonas del TGI.
También es posible aprovechar las propiedades antimicrobianas del cobre mediante el uso de hidroximinerales que son menos reactivos con otros ingredientes y al ser de lenta liberación permiten su uso en altas dosis. En el caso de ponedoras, se ha tenido éxito utilizando cobre en intervalos no continuos.
Los probióticos introducen microorganismos beneficiosos en el TGI, los prebióticos promueven su crecimiento y los simbióticos son el resultado de la combinación de ambos.

Por último, cualquier afección del TGI superior que afecte la adecuada función de alguno de sus órganos repercutirá en la digestión y por ende en la integridad intestinal.
Por lo tanto, se debe prestar atención a la calidad del despique, presencia de úlceras en boca, proventriculitis o erosiones de molleja (Fotos 4 y 5).

Foto 4. Despique mal hecho que compromete el adecuado consumo de nutrientes en el ave.
Los fitogénicos varían según su composición, muchos de ellos tienen propiedades antimicrobianas, inmunoestimulantes y/o antiinflamatorias. También se han utilizado como estimulantes del apetito, jugos gástricos, pancreáticos, antioxidantes y como protectores de la pared intestinal.
Algunos son muy volátiles y se absorben en el primer tramo del TGI, por lo cual deben ser protegidos para mantener su efectividad.
Estrategias para enfrentar desafíos intestinales en postura DESCÁRGALO EN PDF
Foto
Proventriculitis que interfiere en la secreción de ácido clorhídrico y adecuado funcionamiento del proventrículo.
El manejo preventivo y el enfoque integral son fundamentales para mantener la integridad intestinal en las aves de producción y minimizar los problemas de salud y rendimiento asociados.

 5.
5.





Como líder mundial en incubación, Petersime se dedica a ofrecer soluciones que satisfagan las necesidades en constante evolución de los clientes actuales y potenciales en diversos mercados y zonas geográficas. La renovada presencia en línea de la empresa es otro ejemplo de ese compromiso.
El nuevo sitio web corporativo de Petersime cuenta con un diseño renovado, funciones mejoradas y acceso rápido a información fundamental.
Gracias a una interfaz fácil de utilizar y a las sencillas opciones de navegación, los usuarios actuales y potenciales pueden encontrar de forma eficiente toda la información que necesitan sobre las soluciones y los servicios de Petersime.
Pueden descubrir toda la gama de soluciones inteligentes para plantas de incubación, como incubadoras, software, sistemas de climatización, equipos para plantas de incubación, soluciones «llave en mano» y mucho más.
Además, el nuevo sitio web incluye recursos como artículos especializados y noticias interesantes, así como historias de éxito de clientes de todo el mundo. La sección dinámica del blog en la página de inicio ofrece acceso rápido a los artículos más recientes para que la experiencia del usuario sea lo más sencilla posible.



Con un diseño pensado para una audiencia global, la amplia descripción de casos ilustra la presencia mundial de Petersime, que da servicio a plantas de incubación de todo tipo y en todos los mercados del mundo.
Los visitantes pueden echar un vistazo a la extensa lista de plantas de incubación y encontrar casos inspiradores con necesidades similares a las suyas. Además, el sitio incluye formularios fáciles de usar, lo que permite a los visitantes ponerse en contacto con Petersime de forma rápida y sencilla.
Petersime es conocida por su gran dedicación a la innovación y siempre está pensando en nuevas formas de aportar excelencia a sus soluciones. Nuestro sitio web corporativo no es una excepción.

Nos complace presentar este nuevo sitio centrado en el usuario, que ayuda a los clientes actuales y potenciales a encontrar soluciones y servicios para hacer frente a los retos de su negocio, afirmó Olav Boel, Director Comercial de Petersime.
El nuevo sitio web corporativo ofrece un acceso rápido a toda la información relevante sobre la exclusiva cartera de soluciones y servicios de Petersime.
Añadió: “Nuestro nuevo sitio web también ayuda a articular claramente lo que hacemos, cómo lo hacemos y el valor añadido que podemos aportar a los clientes”.
El nuevo sitio web global se puede encontrar en la conocida dirección de www.petersime.com . A finales de este año, se añadirán otros cinco idiomas, con direcciones web con sus respectivas abreviaturas lingüísticas.
El nuevo portal MyPetersime es un elemento clave de la estrategia digital de Petersime: la empresa sigue evolucionando para atender mejor a sus clientes. El objetivo principal de MyPetersime es ofrecer comodidad a los clientes con una experiencia digital eficiente.

MYPETERSIME
En el portal MyPetersime, los clientes obtienen una visibilidad completa de su colaboración con Petersime. Un panel de control claro les permite encontrar rápidamente toda la información relevante para su planta de incubación específica en un solo lugar:
Información de contacto
Documentación sobre mantenimiento
Base de conocimientos
Vista general de cursos de formación
E-shop de piezas de repuesto
Software Eagle Trax™ y mucho más
El inicio de sesión único permite a los usuarios acceder a todo en un único centro digital sin necesidad de recordar una contraseña para cada aplicación.
Los contenidos están claramente
En lo que para nosotros es una primicia para la industria, MyPetersime proporciona a los clientes acceso en tiempo real a un conjunto de opciones de asistencia que les ayudarán a maximizar el rendimiento de su planta de incubación.
Al hacer esta transformación, estamos aprovechando el poder de la digitalización para garantizar que nuestros clientes disfruten de la mejor experiencia en línea posible.
Todo esto, combinado con nuestro marco de atención al cliente existente, nos permite seguir con el objetivo de ser un socio de por vida con el mayor compromiso posible de atención al cliente”, afirmó Kurt Haeck, Director de Atención al Cliente Global de Petersime.
El nuevo portal para clientes se encuentra en www.mypetersime.com y está disponible en inglés, francés, español, portugués, ruso y chino.

MyPetersime se ha diseñado para tener un impacto inmediato, pero también está listo para una futura expansión: seguirá evolucionando con funcionalidades mejoradas y contenido El portal se ampliará con nuevas funciones en los próximos meses.
cuenta con un panel de control intuitivo que permite a los clientes encontrar toda la información relacionada con su planta de incubación en un solo lugar.
Por último, Petersime también lanza un sitio web específico para el empleo. Este nuevo sitio no se centra en las soluciones y servicios de la empresa, sino en Petersime como un empleador relevante.
Petersime ofrece plantas de incubación «llave en mano», equipos para plantas de incubación e incubadoras de primer nivel, así como los conocimientos técnicos y la asistencia necesarios para maximizar la rentabilidad de las inversiones.
Durante más de 100 años, el objetivo de Petersime ha sido utilizar la naturaleza como referencia para seguir perfeccionando el proceso de incubación y ayudar a los clientes a alcanzar el máximo rendimiento.
Este sitio de empleo facilita a los candidatos descubrir las oportunidades profesionales existentes y también cuenta cómo es trabajar en Petersime. Entre otras cosas, muestra a varios empleados que cuentan cómo es su trabajo diario en la empresa.
Además, Petersime lidera el camino en la optimización de la cadena de valor avícola mediante el uso de big data. Con sede en Bélgica y con centros regionales situados en lugares estratégicos, las incubadoras, las soluciones para plantas de incubación y los servicios de Petersime están disponibles en todo el mundo.
Petersime tiene 350 empleados repartidos por todo el mundo y ofrece a estudiantes, graduados y profesionales experimentados oportunidades, desde la producción hasta la logística, desde la ingeniería hasta la biotecnología y desde la cadena de suministro hasta las ventas, entre otros sectores. Visite el nuevo sitio web en inglés o neerlandés en careers.petersime.com .
El nuevo sitio de empleo ofrece un resumen de las oportunidades profesionales de Petersime y cuenta cómo es trabajar en Petersime.
Si desea obtener más información acerca de este tema, póngase en contacto con:
Joke Vuylsteke, coordinador de Marketing
Correo electrónico: joke.vuylsteke@petersime.com
Tres lanzamientos conjuntos: Petersime presenta su nuevo sitio web corporativo, el portal para clientes y el sitio web de empleo
 DESCÁRGALO EN PDF
DESCÁRGALO EN PDF
Experimente las últimas innovaciones, soluciones para su negocio y una formación de primera clase, a la vez que se relaciona con otros profesionales de la alimentación animal, producción de carne, aves y huevos de todo el mundo. Todo está en IPPE 2024. ¡Usted también debería estar!
30 DE ENERO - 1 DE FEBRERO DE 2024
ATLANTA, GA EE.UU
ippexpo.org



Juan D. Latorre1, Sakine Yalçin2, Guillermo Tellez-Isaias1, Hafez M. Hafez3 et al.
1Departamento de Ciencia Avícola, Universidad de Arkansas, EE.UU.
2Departamento de Nutrición Animal y Enfermedades Nutricionales, Facultad de Medicina Veterinaria, Universidad de Ankara, Turquía
3Instituto de Enfermedades Avícolas, Facultad de Medicina Veterinaria, Universidad Libre de Berlín
En los sistemas modernos de producción animal es fundamental minimizar los impactos de la inflamación crónica y el estrés excesivo que los pollos puedan utilizar su energía para crecer en lugar de defenderse.
Aunque no existe una “bola mágica” para prevenir las condiciones multifactoriales asociadas con el estrés crónico, numerosos estudios han demostrado que los productos alternativos, como los probióticos microbios dirigidos, los prebióticos y los fitoquímicos, pueden ayudar a mejorar el equilibrio microbiano intestinal, el metabolismo y la integridad intestinal.

Los probióticos en dosis adecuadas el equilibrio microbiano intestinal, la resistencia a la colonización contra las infecciones y las respuestas inmunológicas.
Lactobacillus spp., Streptococcus thermophilus, Enterococcus faecalis Bifidobacterium spp. son las bacterias del ácido láctico (BAL) más utilizadas en las formulaciones de probióticos. Los posibles mecanismos de acción incluyen:
Mantener un equilibrio saludable de bacterias en el intestino por exclusión competitiva, es decir, en un proceso mediante el cual las bacterias beneficiosas excluyen a las bacterias patógenas potenciales a través de la competencia vía sitios de adherencia en los intestinos y los nutrientes.
Prevenir el crecimiento excesivo de bacterias en el intestino.

mejoran al usar probióticos.
Recientemente se estudió un probiótico comercial a base de bacterias del ácido para uso en aves de corral. Mediante el uso de este cultivo BAL, una amplia investigación de laboratorio y de campo ha demostrado una mayor resistencia a Salmonellas, infecciones en gallinas y pavos.
Varias cepas de probióticos mejoraron el rendimiento de los animales y podrían utilizarse como posibles alternativas a los antibióticos.
Competencia por nutrientes
Competición por los espacios de adhesión
Estimulación inmune
Antagonismo directo
Micro ora intestinal Organismo probiótico Organismo patógeno Célula inmunológica
Figura 1. Mecanismo de acción de los probióticos frente a la presencia de patógenos a nivel intestinal.Higgins et al. informaron que los probióticos redujeron la diarrea idiopática en los galpones de crianza de pavos comerciales, según los ensayos experimentales y comerciales publicados. Además, se demostró que la mezcla de probióticos mejora el rendimiento y reduce los costos de producción en experimentos comerciales a gran escala.

Las aves tratadas con probióticos demostraron variaciones en la expresión génica relacionadas al complejo del factor nuclear kappa B (NF--B), según investigaciones recientes de microarrays.







Estos hallazgos indican que los cultivos de probióticos específicos en ocasiones pueden ser una alternativa atractiva a la terapia antibiótica tradicional.
Con urgencia se necesitan probióticos comerciales que sean de larga duración, costo efectivo y resistencia al proceso de peletización por calor para promover el cumplimiento y un uso más amplio.
Algunos productos probióticos contienen formadores de esporas bacterianas, típicamente del género Bacillus. Se ha comprobado que algunos (pero no todos) previenen ciertos problemas gastrointestinales.

La variedad de especies empleadas y sus múltiples usos son asombrosas.
Estos medios demuestran el beneficio que algunos aislados de esporas de Bacillus son las esporas más tolerantes al calor conocidas y, por lo tanto, también pueden emplearse en circunstancias de calor intenso.
Por lo tanto, las esporas de cepas seleccionadas de Bacillus se han utilizado como microorganismos de alimentación directa (DFM) confiables en la producción animal debido a su capacidad para soportar condiciones ambientales adversas y largos períodos de almacenamiento.
Los ensayos de campo sugirieron que una cepa aislada de esporas de Bacillus subtilis es eficaz como probiótico comercial a base de bacterias del ácido láctico para reducir Salmonella spp. La investigación adicional puede revelar más aislados potentes o combinaciones de aislados.
Algunos de estos aislamientos ambientales de Bacillus han sido probados in vitro en cuanto a actividad antibiótica, estabilidad al calor y crecimiento de la población.
Mejorar la eficiencia de la amplificación y la esporulación es fundamental para obtener la aprobación industrial de un probiótico basado en alimento para la intervención ante mortem de patógenos transmitidos por los alimentos.
Un crecimiento vegetativo y una tasa de esporulación mejorada pueden conducir a nuevas eficiencias para la amplificación comercial y la creación de productos rentables con recuentos de esporas muy altos.
El aumento de la viscosidad de la digesta y el mayor tiempo de paso del alimento causado por las altas concentraciones de polisacáridos no amiláceos (NSP) solubles en las dietas de las aves influyen en la población bacteriana intestinal.
Por lo tanto, las carbohidrasas exógenas (xilanasa, glucanasa, mananasa, galactosidasa y pectinasa) se utilizan como aditivos alimenticios en un intento por reducir el impacto negativo de estos factores antinutricionales.
También se ha demostrado que los Bacillus-DFM previenen trastornos del TGI y brindan una variedad de beneficios nutricionales tanto para animales como para humanos. Los estudios in vitro e in vivo han demostrado que el 90% de las esporas de B. subtilis germinan en diferentes segmentos del TGI dentro de los 60 minutos en presencia de alimento.
Además, al usar diferentes dietas para aves de corral in vitro (dietas basadas en centeno, trigo, cebada y avena).
Donde la inclusión de candidatos seleccionados de Bacillus-DFM que producen un conjunto diferente de enzimas extracelulares.
Resultó en una reducción significativa tanto en la viscosidad digesta como en la proliferación de Clostridium entre el control y las dietas suplementadas con Bacillus-DFM.
Curiosamente, se demostró que la suplementación con DFM basado en Bacillus mejoró el rendimiento del crecimiento, la viscosidad digesta, la translocación bacteriana, la composición de la microbiota y la mineralización ósea en pollos de engorde y pavos alimentados con una dieta basada en centeno.
Estas diferencias se pueden deber a la menor cantidad de sustratos disponibles para el crecimiento bacteriano, lo que resultó en una menor inflamación intestinal y translocación bacteriana cuando se redujo la viscosidad intestinal al incluir el candidato DFM, lo que implica que los grupos suplementados absorbieron más nutrientes en el borde en cepillo del intestino.


Las mejoras significativas en el rendimiento observadas en pavos y pollos alimentados con la dieta suplementada con Bacillus-DFM en comparación con el grupo de control sin suplementos sugiere que:


Incrementar la absorción de nutrientes;
Los prebióticos son un concepto relativamente reciente, surgiendo de la idea que los elementos alimenticios no digeribles (p. ej., los oligosacáridos no digeribles) son fermentados selectivamente por bacterias conocidas para beneficiar la función intestinal.
La producción de enzimas a partir de las cepas combinadas de Bacillus spp utilizadas como DFM puede:
Promover el rendimiento del crecimiento y una tasa de conversión alimenticia más eficiente;

Además de mejorar la integridad intestinal.
Asimismo, se demostró que el DFM reduce significativamente la gravedad de las infecciones experimentales por Salmonella entérica subespecie enterica serotipo Enteritidis y la aflatoxicosis.

En un estudio, se demostró que la translocación bacteriana, la viscosidad intestinal, la composición de la microbiota y la mineralización ósea en pollos de engorde se ven afectados por el uso de energía del centeno. Sin embargo, Bacillus-DFM revierte los efectos negativos de las dietas altas en NSP en las aves de corral.
Además, el rendimiento de los pollos de engorde y los pavitos mejoró con la inclusión de DFM en las dietas reducidas en grasas, lo que se asoció con una mayor digestibilidad de la energía medida por la energía metabolizable
Se ha demostrado que la proliferación de bacterias endógenas de ácido láctico y bifidobacterias en el intestino beneficia la salud del huésped.
Los prebióticos pueden ayudar a las bifidobacterias y los lactobacilos a proliferar en el intestino, mejorando el equilibrio microbiano del huésped.
Los prebióticos, a diferencia de los probióticos, fomentan a las bacterias intestinales que se han aclimatado al entorno del tracto gastrointestinal.
La microbiota intestinal saludable puede aumentar la absorción, el metabolismo de las proteínas, el metabolismo energético, la digestión de la fibra y la maduración intestinal en ratones resistentes a la leptina.
También se ha demostrado que los prebióticos mejoran la defensa del huésped



La capacidad de los prebióticos para aumentar la cantidad de BAL en el intestino puede ayudar en la exclusión competitiva de patógenos del tracto gastrointestinal de las aves.
En tanto, el aumento de la acidez intestinal causado por los prebióticos también puede ayudar a reducir las infecciones en el intestino de los pollos.

También se ha demostrado que los prebióticos aumentan la respuesta inmunológica en los pollos, lo que resulta en una eliminación más rápida de la infección.

Por ejemplo, los prebióticos pueden interactuar directamente con las células inmunitarias intestinales o interactuar indirectamente con las células inmunitarias a través de la colonización de bacterias beneficiosas y metabolitos microbianos preferidos.
Los prebióticos pueden funcionar de manera similar a los probióticos para apoyar la salud intestinal de los pollos. Los prebióticos más utilizados en aves de corral son:
Inulina;
Fructooligosacáridos (FOS);
Mananooligosacáridos (MOS);
Galactooligosacáridos (GOS);
Oligosacáridos de soja (SOS);
Xilooligosacáridos (XOS);
Pirodextrinas;
Isomaltooligosacáridos (IMO); y
Lactulosa.
La investigación de prebióticos en aves de corral se ha llevado a cabo desde 1990, resultando en una gran biblioteca de estudios. Los prebióticos en los alimentos para pollos de engorde se ha demostrado que aumentan los niveles de lactobacilos.
Algunos estudios sobre los efectos microbianos de la suplementación con prebióticos encontraron un aumento de las bifidobacterias y una disminución de los clostridios. Mientras, en otros la Salmonella y los coliformes se redujeron.

También se ha demostrado que el uso de prebióticos aumenta la altura de las vellosidades intestinales en las dietas de pollos de engorde, según la morfología intestinal. En tanto, los procesos de desintoxicación y eliminación se ven reforzados por una población saludable de estas bacterias útiles en el tracto digestivo.
Asimismo, se ha demostrado que los prebióticos mejoran la calidad de la cáscara y ósea, incrementan la utilización de minerales y mejoran el rendimiento en gallinas ponedoras.

Un prebiótico de uso frecuente concierne a Aspergillus oryze, que se comercializa como harina de Aspergillus (MA). La MA incluye 16% de proteína y 44% de fibra y se puede usar para mejorar el rendimiento en dietas comerciales para aves con bajos niveles de proteína.
El micelio o A. oryzae también contiene betaglucanos, FOS, quitosano y MOS. Esta sustancia también beneficia a los pollos al promover el crecimiento, muy probablemente a mejorar la absorción y digestibilidad de los ingredientes del alimento.
El beta-glucano es un potente refuerzo de la inmunidad. Esta sustancia única afecta las vellosidades intestinales y ayuda al cuerpo a combatir los invasores virales y bacterianos.
Los MOS se unen a los sitios activos de la toxina y defienden el TGI contra la invasión.
Los FOS y el quitosano son carbohidratos no digeribles que son fermentados fácilmente por la flora intestinal.
Se demostró que la harina de Aspergillus (MA) dietética altera la morfometría intestinal en pavitos. Esta incrementó el número de células de mucina ácida, células de mucina neutra y células de sulfomucina en el duodeno y el íleon.
Además de la altura y el área de superficie de las vellosidades en el duodeno y el íleon de los pavitos recién nacidos en comparación con el control.
Otro estudio encontró que alimentar a los pavitos recién nacidos con prebióticos MA durante 30 días aumentó el peso corporal y mejoró la conversión alimenticia en comparación con alimentarlos con una dieta de control basal.
Curiosamente, los pollitos alimentados con prebióticos AM en la dieta tenían menor contenido de proteína y energía en el íleon que los pollitos de control, lo que indica una mayor digestión y absorción de esos nutrientes.
Los fructooligosacáridos (FOS) han demostrado que mejoran la absorción intestinal de calcio y magnesio, además de las concentraciones de minerales óseos.
Varios estudios han demostrado que los probióticos pueden reducir la colonización de Salmonella en las gallinas.

Finalmente, el quitosano es un biopolímero natural creado por la desacetilación de la quitina, el principal componente de las paredes celulares de los hongos y los exoesqueletos de los artrópodos. Como se indicó anteriormente, el quitosano tiene varios beneficios, incluidas las propiedades antimicrobianas y antioxidantes.
También, el quitosano ha mostrado aplicaciones prometedoras en la agricultura, horticultura, ciencias ambientales, industria, microbiología y medicina. Además, muchos estudios han utilizado quitosano como adyuvante de la mucosa, aumentando los niveles de IgA.
En otro estudio, se evaluó en pavos y gallinas la eficacia del 0,2% de MA en la dieta contra la transmisión horizontal de Salmonella spp. Este estudio encontró que la alimentación de pavos y pollos de engorde con 0,2% de MA redujo la transmisión horizontal de Salmonella Enteritidis y Typhimurium al reducir los niveles generales de colonización.
La reducción de la colonización por Salmonella puede atribuirse a un efecto sinérgico de beta-glucano, MOS, quitosano y FOS que se encuentran en el micelio de Aspergillus oryzae.

Cuando se usa una combinación de prebióticos y probióticos se denominan simbióticos y tienen la capacidad de mejorar aún más la viabilidad de los probióticos. Los probióticos, prebióticos y simbióticos ahora se usan ampliamente en todo el mundo. En la siguiente sección, discutimos el papel de los simbióticos en la fisiología digestiva y la producción avícola.
Yalçın et al. informaron que la pared celular de levadura derivada de la levadura de panadería era un aditivo prebiótico eficaz en la alimentación de pollos de engorde, debido al aumento del rendimiento del crecimiento, el aumento de la respuesta inmune humoral y la reducción de la grasa abdominal.
En otro estudio realizado con gallinas ponedoras, Yalçın et al. concluyó que la pared celular de la levadura tenía efectos beneficiosos en la producción de huevos bajos en colesterol y una mejora en la respuesta de la inmunidad humoral.
Exclusión competitiva
Reducción de amoníaco
Producción de vitaminas y mantenimiento del pH intestinal
Actividad antimicrobiana
Inmunomodulación (simulación/tolerancia)
Producción de enzimas
Integridad de la barrera epitelial; Diversidad y equilibrio de la microbiota
Inmediatamente después de la eclosión, las aves deben cambiar la energía endógena - los lípidos del vitelo –a la energía de una dieta exógena rica en carbohidratos. Durante este período vital, el tamaño y la morfología del intestino cambian drásticamente. Los cambios en las membranas de las células epiteliales alteran la interfaz mecánica entre el ambiente interno del huésped y el contenido luminal.

Los estudios sobre la nutrición y el metabolismo del crecimiento temprano en pollitos pueden ayudar a optimizar el manejo nutricional para un crecimiento óptimo.
Los productos finales digeridos por los microorganismos intestinales simbióticos pueden modificar no sólo la dinámica intestinal, sino también varios sistemas fisiológicos.
Las múltiples funciones de los simbióticos en la fisiología digestiva se resumen en la Figura 2.
Probiótoco Prebiótico
Figura 2. El papel de los simbióticos en la fisiología digestivaLos aditivos fitogénicos para alimentos balanceados (PFA) se clasifican como compuestos sensoriales y aromatizantes de acuerdo con la legislación de la Unión Europea (EC 1831/2003).
Se ha sugerido que los PFA aumentan el rendimiento del crecimiento, la digestibilidad de los nutrientes y la salud intestinal en las aves de corral.
Actualmente, los PFA se utilizan en programas de alimentación de aves y cerdos. El recuento de Lactobacillus spp en el ciego aumentó cuando se añadieron 75 mg/kg de polvo de raíz de ginseng rojo como suplemento.
Varios productos comerciales se basan en hierbas como:
Estas sustancias fitogénicas se promueven, debido a sus perfiles de seguridad y cualidades para mejorar el rendimiento y la salud de los animales, a través de los siguientes efectos:
Mejora de la digestibilidad;
Actividades antimicrobianas;
Efectos antiinflamatorios y antioxidantes;

Estabilización de la microbiota intestinal;

Mejora de las características de los animales; y
Reducción de las emisiones ambientales.
Además de los efectos farmacológicos, estudios recientes indicaron que las sustancias fitogénicas modulan la microbiota intestinal, es decir, aumentan Firmicutes, Clostridiales, Ruminococcaceae y Lachnospiraceae

Semillas de anís (Pimpinella anisum); Hojas de melisa (Melissa officinalis);
Semillas de alcaravea (Carum carvi); Bulbos de cebolla (Allium cepa);
Corteza de canela (Cinnamomum verum); Hojas de orégano (Origanum vulgare);
Flores de manzanilla (Matricaria recutita); Hojas de menta piperita (Mentha piperita);
Cáscara de cítricos (Citrus sp); Hojas de romero (Rosmarinus officinalis);
Brotes de clavo (Syzygium aromaticum); Hojas de salvia (Salvia officinalis);
Semillas de hinojo (Foeniculum vulgare); Hojas de tomillo (Thymus vulgaris); y
Bulbos de ajo (Allium sativum);
Rizoma de jengibre (Zingiber officinale);
Raíz/rizoma de valeriana (Valeriana officinalis).
Bacteroides

Sacarolítico, proteolítico Síntesis de biotina, riboflavina, pantotenato y ascorbato
Prevotella Degradación de mucina/glucoproteína Síntesis de tiamina y folato.
Ruminococo Degradación de mucina/glucoproteína. Transporte transmembrana de azúcares
Proteínas y grasas
Azúcares
Diversos factores pueden modular la microbiota intestinal causando un efecto positivo o negativo en el huésped. Los efectos de la dieta sobre la composición del microbioma se muestran en la Tabla
1. La suplementación de pollos de un día con antibióticos moduló negativamente la microbiota intestinal y afectó negativamente el desarrollo del sistema inmunológico.
También se descubrió que cambiar la dieta de maíz a trigo y cebada condujo a un aumento de Lactobacillus y coliformes. Los polisacáridos no amiláceos solubles en agua aumentaron la viscosidad del contenido digestivo y la producción de AGCC, lo que reguló de manera beneficiosa la motilidad ileal.
Para prevenir las condiciones multifactoriales asociadas con el estrés crónico, numerosos estudios han demostrado que los productos alternativos, como los probióticos, los microbios dirigidos, los prebióticos y los fitoquímicos, pueden ayudar a mejorar el equilibrio microbiano intestinal, el metabolismo y la integridad intestinal.
Se ha corroborado que estos aditivos alimenticios tienen características antiinflamatorias, antioxidantes, inmunomoduladoras y que mejoran la integridad de la barrera.
Probióticos, prebióticos y sustancias fitogénicas para optimizar la salud intestinal en avicultura. Parte II
DESCÁRGALO EN PDF
Para cumplir con sus objetivos de salud y productividad, los avicultores que han eliminado los antibióticos de sus sistemas de producción pueden utilizar una combinación de productos alternativos junto con métodos de manejo mejorados, bioseguridad rigurosa y programas de inmunización efectivos.
Tabla 1. Efecto de la dieta sobre la composición del microbioma.Los beneficios del concepto Ziggity para reproductoras pesadas incluyen:




• Una mejora dramática en la uniformidad, viabilidad y performance de los machos
• Pisos y camas secos significan casi cero amoníaco emitido al ambiente
• Mejor bienestar de las aves
• Mayor número de huevos incubables y pollitos nacidos
• No hay necesidad de copitas llenas de bacterias

 Volker Altenbokum
Director de Desarrollo de Negocios Internacionales
Volker Altenbokum
Director de Desarrollo de Negocios Internacionales
valtenbokum@biozymeinc.com
Alan Lee Director de Desarrollo de Negocios Nacionales alee@biozymeinc.comEquipo técnico de BioZyme® Inc.
Mundialmente, la producción de huevos está ganando popularidad e importancia. Esto está principalmente impulsado por el aumento del consumo de huevos, y va acompañado de algunos desafíos que los productores deben superar para satisfacer las demandas de los consumidores para seguir teniendo una operación rentable.
Los desafíos más urgentes están relacionados con la calidad de la cáscara de huevo y la vida productiva de las gallinas.
Mantener una fisiología normal y una buena salud de la gallina ponedora es esencial para producir huevos de alta calidad durante períodos más largos.
Realizar intervenciones dietéticas como la incorporación en la dieta de alimentos fermentados, fibra, probióticos, prebióticos y postbióticos son medios aceptables para influir en el microbiota intestinal y su actividad metabólica.
En gallinas ponedoras, se ha investigado la inclusión de postbióticos en la dieta para mantener/mejorar la productividad y la calidad del huevo, lo cual ha llevado al desarrollo y comercialización de un nuevo producto, AO-Biotics® EQE (Egg Quality Enhancer).

De Juan et. al. (2021 y 2022) estudiaron los efectos de AO-Biotics EQE en el rendimiento y los rasgos de calidad del huevo de gallinas de 15 a 43 y de 18 a 65 semanas de edad.

Los resultados de estos estudios, junto a numerosas evidencias provenientes de ensayos de campo bajo condiciones comerciales, demostraron que la adición de AO-Biotics EQE aumentó en promedio:
Los huevos comercializables en un 3%
La masa de huevos en un 2%
La producción de huevos en un 3%
Y disminuyó la mortalidad acumulada alrededor del 25%
AO-Biotics EQE es un postbiótico fúngico producido a través de una pendiente de patente y específicamente indicado para mejorar el número de huevos comercializables, la masa de huevos y la vida útil productiva de las gallinas ponedoras.
En general, cuantos más huevos pueda comercializar una operación, mayor será el potencial de beneficio.
La producción de huevos está influenciada por una variedad de factores, incluida la calidad del alimento, el entorno en el que se mantienen las gallinas y la salud de estas. Esos factores pueden afectar la producción, el tamaño y la calidad del huevo, lo que a su vez puede afectar los ingresos y la rentabilidad.

Además, una alta mortalidad acumulada puede conducir a grandes pérdidas económicas. Para maximizar la rentabilidad, los productores de huevos deben:
Esforzarse por optimizar la productividad de sus gallinas, aumentar su tasa de supervivencia y mantener o mejorar la calidad de la cáscara del huevo, ayudando a los animales a producir más huevos vendibles. Para lograr esto, los productores necesitan emplear un sistema de gestión apropiado que, entre otros aspectos, podría incluir el uso de postbióticos como AO-Biotics EQE.
BioZyme® Inc., el creador de AO-Biotics EQE, ha creado una herramienta para ayudar a los productores a evaluar el potencial y las ventajas de incorporar AO-Biotics EQE en sus programas de alimentación.
AO-Biotics EQE es el primer y único posbiótico de AO desarrollado específicamente para gallinas ponedoras, utilizando tecnología pendiente de patente.

La misma incluye:
Número de gallinas ponedoras en el galpón o nave
Precio de las pollitas y edad de las pollitas en el momento de la entrada a producción
Semanas de edad al final del ciclo de puesta
Mortalidad acumulada prevista en el grupo de gallinas
Costo de alimentación ($/TM)
Consumo medio diario por animal (g/d)
Tasa de producción en porcentaje (promedio a lo largo del ciclo de producción)
Número de huevos puestos por gallina en el ciclo de producción
Precio/costo del huevo por huevo o costo por kg
Esta herramienta también considera el costo de agregar AO-Biotics EQE a la dieta. A la tasa de inclusión recomendada de 50 mg / TM, el costo total de AOBiotics EQE representará menos de un 1% de aumento en el costo de alimentación.
Completando la información descrita anteriormente, podremos ver que el beneficio esperado de agregar
AO-Biotics EQE (más masa de huevos, más huevos vendibles, y mayor vida productiva) en el programa de alimentación, proporcionará un retorno de la inversión (RI) significativo.
Un ejemplo práctico es:

600 mil gallinas entrando en los galpones/naves de producción a las 18 semanas de edad
Un ciclo de producción hasta las 100 semanas de edad
Una mortalidad acumulada esperada del 6%
Un consumo medio diario por animal de 115 g de alimento/d
Una tasa media de producción de 88%
Una expectativa de 450 huevos/gallina a las 100 semanas de edad con un peso medio de 62 g por huevo
Con los parámetros expuestos anteriormente, se esperaría que 36.000 gallinas murieran a lo largo del ciclo productivo.

La primera ventaja de AO-Biotics EQE es una mejora en la vida productiva de la parvada, reduciendo la mortalidad acumulada en un 25%.
Es decir, la mortalidad acumulada se reduciría a un 4,5% (9.000 gallinas más produciendo huevos por un período más largo).
La segunda ventaja es más masa de huevos, junto con una mejora en la persistencia de la producción de huevos a lo largo del tiempo.
La mejora de la productividad y la vida productiva de la parvada se reflejará en una mejora en el número de huevos vendibles (3% más).
En este caso, el aumento en los huevos vendibles significará 14 huevos más por gallina en producción. Teniendo en cuenta esta mejora en combinación con los ahorros derivados del aumento de la vida productiva de las ponedoras, los productores pueden esperar un RI del orden de 6:1.

Si es así, visite Biozymeinc.com/additive/eqe/ para obtener más información sobre la incorporación de AO-Biotics EQE en su operación.


También puede calcular su propio RI en función de sus costos de operación utilizando nuestra calculadora de retorno económico AO-Biotics EQE en línea, o contactando a uno de nuestros representantes para que lo ayude a realizar la evaluación económica.
¡Por lo que vale! Nuevo postbiótico genera un retorno económico en gallinas ponedoras
DESCÁRGALO EN PDF
 VISITAR LA WEB
VISITAR LA WEB
El primer y único postbiótico de AO para gallinas ponedoras, utilizando tecnología pendiente de patente.
Obtén más huevos comercializables, más masa de huevo y extiende la vida productiva de las gallinas con AO-Biotics EQE. Basado en los 70 años de experiencia de BioZyme en fermentación con Aspergillus oryzae (AO) para ofrecer productos que mejoran la salud, el bienestar y la productividad de los animales. Expertos en AO. El Menos Común de Todos.

Donde la atención es un círculo completo.
BioZymeInc.com
GREEN START e s un innovador modelo diseñado para abordar los desafíos que enfrentan los avicultores durante la fase de cría-recría en aviarios.
El objetivo principal de este sistema es lograr resultados óptimos en términos de uniformidad del lote, baja mortalidad y un excelente ratio de conversión consumo de alimento/peso ave, todo ello en un entorno saludable para las pollitas.
Además, GREEN START está diseñado para facilitar el manejo de las aves en las diferentes etapas del proceso de cría-recría.


 Equipo Técnico ZUCAMI
Equipo Técnico ZUCAMI
Una de las características distintivas de nuestro modelo GREEN START es su enfoque en el entrenamiento de las futuras ponedoras para lograr resultados de producción sobresalientes durante la etapa de puesta.
El diseño del sistema se ha concebido de manera que brinde a las aves la superficie y los elementos ideales para desarrollar todas sus capacidades y tener un buen arranque en la etapa de producción. Este modelo ha sido creado para tener una larga vida útil y ha sido diseñado con elementos de excelente calidad y solidez.

De la misma manera, las pollitas que se crían en GREEN START reciben el entrenamiento adecuado para poder orientarse de forma natural en el aviario de puesta.


Una de las ventajas notables de GREEN START es su durabilidad.
Los materiales utilizados en su construcción garantizan la resistencia y la estabilidad necesarias para soportar el uso continuo y las condiciones propias de un entorno avícola.
La comodidad y la facilidad de uso también son características destacadas de GREEN START.
El sistema está diseñado para permitir una visualización completa de las pollitas durante toda la etapa de cría-recría, lo que facilita el monitoreo y el seguimiento de su desarrollo.
Asimismo, cuenta con 3 niveles de zonas habitables adaptadas a las necesidades específicas de cada fase del ciclo de cría-recría.
Esto asegura un entorno cómodo y seguro para las aves, promoviendo su bienestar y un crecimiento saludable.
En este sentido, la adaptabilidad y movilidad de las aves también son aspectos clave en el diseño de GREEN START.
Desde el primer día, las pollitas pueden moverse libremente dentro del sistema, lo que les permite explorar su entorno y desarrollar sus habilidades naturales.
Esto contribuye a un crecimiento más equilibrado y a un comportamiento más saludable de las aves.
Otra ventaja significativa de GREEN START es su sistema de montaje rápido y fácil acceso.
Los avicultores pueden ensamblar el sistema de manera sencilla y rápida, lo que les permite ahorrar tiempo y esfuerzo.
Al mismo tiempo, el fácil acceso al sistema facilita las tareas de limpieza, mantenimiento y manejo de las aves.


Los resultados obtenidos con GREEN START son excepcionales.

El sistema ha demostrado ofrecer excelentes niveles de uniformidad en el lote, lo que es fundamental para una producción eficiente y rentable.
Adicionalmente, se ha observado una baja tasa de mortalidad y una alta productividad en las aves criadas con GREEN START.
Estos resultados positivos son el fruto de un diseño cuidadoso y de la implementación de prácticas de manejo adecuadas.
El sistema permite una configuración de grupos flexible, lo que facilita la adecuada vacunación, control y manejo de las aves.

Los avicultores tienen la capacidad de organizar y gestionar eficientemente a las pollitas según sus necesidades específicas, lo que contribuye a optimizar la producción y el bienestar de las aves.

 La versatilidad de GREEN START es otro aspecto destacado.
La versatilidad de GREEN START es otro aspecto destacado.
En resumen, GREEN START es un modelo innovador y completo que aborda los desafíos de la cría-recría en aviarios.
Su diseño, durabilidad, comodidad, adaptabilidad, excelentes resultados y versatilidad hacen de este sistema una elección ideal para los avicultores que buscan:
Maximizar la uniformidad
Minimizar la mortalidad
Lograr una alta productividad en sus lotes de aves


Con GREEN START, los avicultores pueden tener la confianza de que están proporcionando a sus pollitas un entorno saludable y óptimo para su desarrollo y rendimiento en la etapa de puesta.
Obtén los mejores resultados durante la cría-recría de una manera eficiente, fácil y segura con GREEN START DESCÁRGALO EN PDF

AVIARIO VISION para GALLINAS PONEDORAS
AVIARIO GREEN WAY para GALLINAS PONEDORAS
AVIARIO GREEN START para CRÍA-RECRÍA
NUEVA WEB


M.V. M.Sc. Dino Garcez e M.V. Letícia Tonoli Braga
Nutricionais S/A
A continuación del primer artículo, en esta sección se abordará el diagnóstico, control y prevención de la Enteritis Necrótica (EN) en aves..
El diagnóstico se realiza analizando el historial de mortalidad del lote, los signos clínicos y los hallazgos de la necropsia asociados a la histopatología donde se verifican las lesiones microscópicas características.
También se puede realizar serología (ELISA) para detectar la toxina, así como el aislamiento del Clostridium perfringens, que se realiza a partir del contenido intestinal (raspados de mucosa o placas de Peyer hemorrágicas). Por último, puede realizarse PCR a partir de muestras de contenido intestinal y/o raspados de mucosa.

En los casos de enteritis, hay fusión de las vellosidades intestinales (foto 1) e hiperplasia de las células caliciformes (foto 2), que son las que producen la mucina, principal componente del moco.

Foto 1 - Fusión de vellosidades en el yeyuno (cada flecha corresponde a una vellosidad). HE, obj.20x. Fuente: Mesa, D. et al., 2014.
Foto 2 - Hiperplasia de células caliciformes en las vellosidades del duodeno (área demarcada). HE, obj.40x. Fuente: Mesa, D. et al., 2014.
El proceso inflamatorio se caracteriza por una migración masiva de heterófilos a las regiones donde se produce la necrosis y una intensa infiltración de leucocitos en la lámina basal, concomitantemente con edema, hiperemia, congestión y hemorragia de la lámina propia, la submucosa y la serosa.
El control de la mortalidad durante los brotes se realiza mediante la administración de antibióticos a través del agua de bebida o del alimento. Entre los principales antibióticos con acción contra los G+ podemos citar las tetraciclinas, la tilosina y la amoxicilina.
Los AMDs controlan la microbiota patógena y reducen la competencia por los nutrientes, además de disminuir la producción de metabolitos depresores del crecimiento en las aves, mejorando así los índices zootécnicos (aumento de peso, conversión alimenticia y mortalidad).

Desde la prohibición de los AMDs en la Unión Europea en 2006, su uso se ha reducido gradualmente en todo el mundo. Esta iniciativa es apoyada por la Organización Mundial de la Salud (OMS) y tiene como objetivo reducir la resistencia a los antimicrobianos (AMR).
En Brasil, varios antimicrobianos han sido descontinuados en la última década, y sólo un pequeño número de AMDs son permitidos por el Ministerio de Agricultura y Abastecimiento (MAPA) para su uso en alimentos balanceados.
A continuación, se enumeran los principales AMDs utilizados en pollos de engorde y sus respectivas dosis:
Avilamicina (2,5 a 10 ppm);
Bacitracina (4 a 55 ppm);
Enramicina (5 a 10 ppm – fases preinicial/ inicial/crecimiento, 3 a 5 ppm final);
Flavomicina (1 a 2 ppm);
Virginiamicina (5,5 a 16,5 ppm);

Químicos: se utilizan tanto de forma terapéutica en casos clínicos como de forma preventiva a través de la alimentación, en programas de aditivos anticoccidianos (diclazuril, toltrazuril, amprolium y nicarbazin).
Ionóforos: se emplean en la prevención de las infecciones por Eimeria mediante su uso continuo a través de la alimentación. Pueden utilizarse aislados o conjugados (salinomicina, monensina, maduramicina, lasalocid y narasina).
Cabe destacar que los ionóforos tienen una acción antimicrobiana con baja probabilidad de generar ADRs, por lo que ayudan en el control de la CP de forma directa.
Pueden prevenir indirectamente las pérdidas por CP, ya que la presencia de especies de Eimeria spp. es un factor predisponente para la EN.
En la actualidad, se dispone de varias opciones de vacunas en todo el mundo, con tecnologías innovadoras de desarrollo y aplicación que permiten seguridad y eficacia en sus resultados.
Se trata de aditivos a base de bacterias, levaduras u hongos que alteran la microbiota intestinal, favoreciendo un equilibrio entre las distintas poblaciones bacterianas beneficiosas que inhibe el desarrollo de bacterias patógenas.
Como resultado, aumentan la integridad intestinal, modulan la inmunidad, lo que se traduce en un mejor rendimiento zootécnico y contribuyen a una mayor seguridad de los productos avícolas.
Entre los géneros bacterianos más utilizados como probióticos se encuentran Bacillus spp., Lactobacillus spp. y Enteroccoccus spp. Además, se utilizan levaduras concentradas de la especie Saccharomyces cerevisae.
Su utilización busca principalmente formar la protección sanitaria del ave mediante la exclusión competitiva, aumentando la respuesta inmunitaria celular y humoral, así como reduciendo la permeabilidad intestinal.
Además, pueden mejorar el rendimiento zootécnico mediante la producción de bacteriocinas y ácidos orgánicos que actúan directamente reduciendo la población de CP, así como enzimas que aumentan la digestibilidad de los ingredientes del alimento.

Son aditivos compuestos por aceites esenciales (AE) y/o extractos vegetales (EV) que presentan efectos antimicrobianos (bacterias, virus y hongos), antioxidantes, antiinflamatorios y digestivos al estimular la producción de enzimas digestivas (por ejemplo, amilasa).

Los AE son mezclas complejas de sustancias volátiles, generalmente lipofílicas, cuyos componentes incluyen terpenos, alcoholes simples, aldehídos, cetonas, fenoles y ésteres.
Los estudios sugieren que los efectos antimicrobianos de los fitógenos (por ejemplo, timol - tomillo, eugenol - romero) sobre bacterias como CP se producen debido al daño directo de la membrana bacteriana, la inhibición enzimática de su metabolismo energético y la desnaturalización de determinadas proteínas. El efecto digestivo observado con su uso (por ejemplo, piperina - pimienta) se produce debido a la estimulación de la producción de enzimas endógenas (por ejemplo, amilasa).
Para mejorar el control de las micotoxinas, es necesario comprender mejor sus mecanismos de acción, sus efectos sobre las aves de corral y disponer de técnicas de diagnóstico más precisas y sensibles.
Además, es recomendable el uso de componentes que no sólo adsorban las micotoxinas, sino que también bloqueen sus efectos y sean capaces de biotransformarlas (por ejemplo, enzimas) en compuestos inocuos para las aves de corral.
Cuando se utilizan en la alimentación animal, mejoran el rendimiento de los animales, pero no tienen ningún efecto medicinal, ni por el principio activo ni por su dosificación.
La presencia de 5.000 ppb de DON en el alimento es un factor predisponente para la EN en pollos de engorde. Esto se debe a los efectos negativos directos de esta micotoxina sobre la barrera intestinal (aumento de la permeabilidad, daño de las microvellosidades) y al consiguiente aumento de la concentración de proteína total en el duodeno, que estimula el crecimiento y la producción de toxinas de CP.
Las dietas a base de cereales como el trigo, el centeno, la avena y la cebada pueden aumentar la incidencia y la gravedad de la EN porque estos cereales tienen altos niveles de polisacáridos no amiláceos (PNA) que aumentan la viscosidad y la producción de moco intestinal. El uso de enzimas nutricionales (por ejemplo, xilanasa), mejora la digestibilidad de estos ingredientes.
Además, los ingredientes con altas concentraciones de proteínas, como la harina de soya (que contiene inhibidores de la proteasa y lectinas), la harina de pescado, la harina de carne y la harina de huesos, pueden contener altos niveles de contaminación por CP.
Revisión Bibliográfica bajo consulta. Para más información diríjase a DSM.

El alimento puede llegar a representar el 70% de sus costos totales de producción. La utilización eficiente de los nutrientes en las aves asegura un desarrollo saludable, impulsa la productividad y mejora el desempeño. Mejorando la eficiencia y la sostenibilidad, dsm-firmenich ayuda a impulsar el desempeño de sus aves y su rentabilidad, con confianza.
Si no nosotros, ¿quién? Si no ahora, ¿cuándo?


Descenso de hasta un 90% de la carga microbiana
Perfecta combinación de tensoactivos, hidróxidos, ácidos y secuestrantes para cada aplicación
Degradan biofilms e incrustaciones de sales imposibles de eliminar sólo con agua





Facilitan el aclarado y la desinfección posterior
